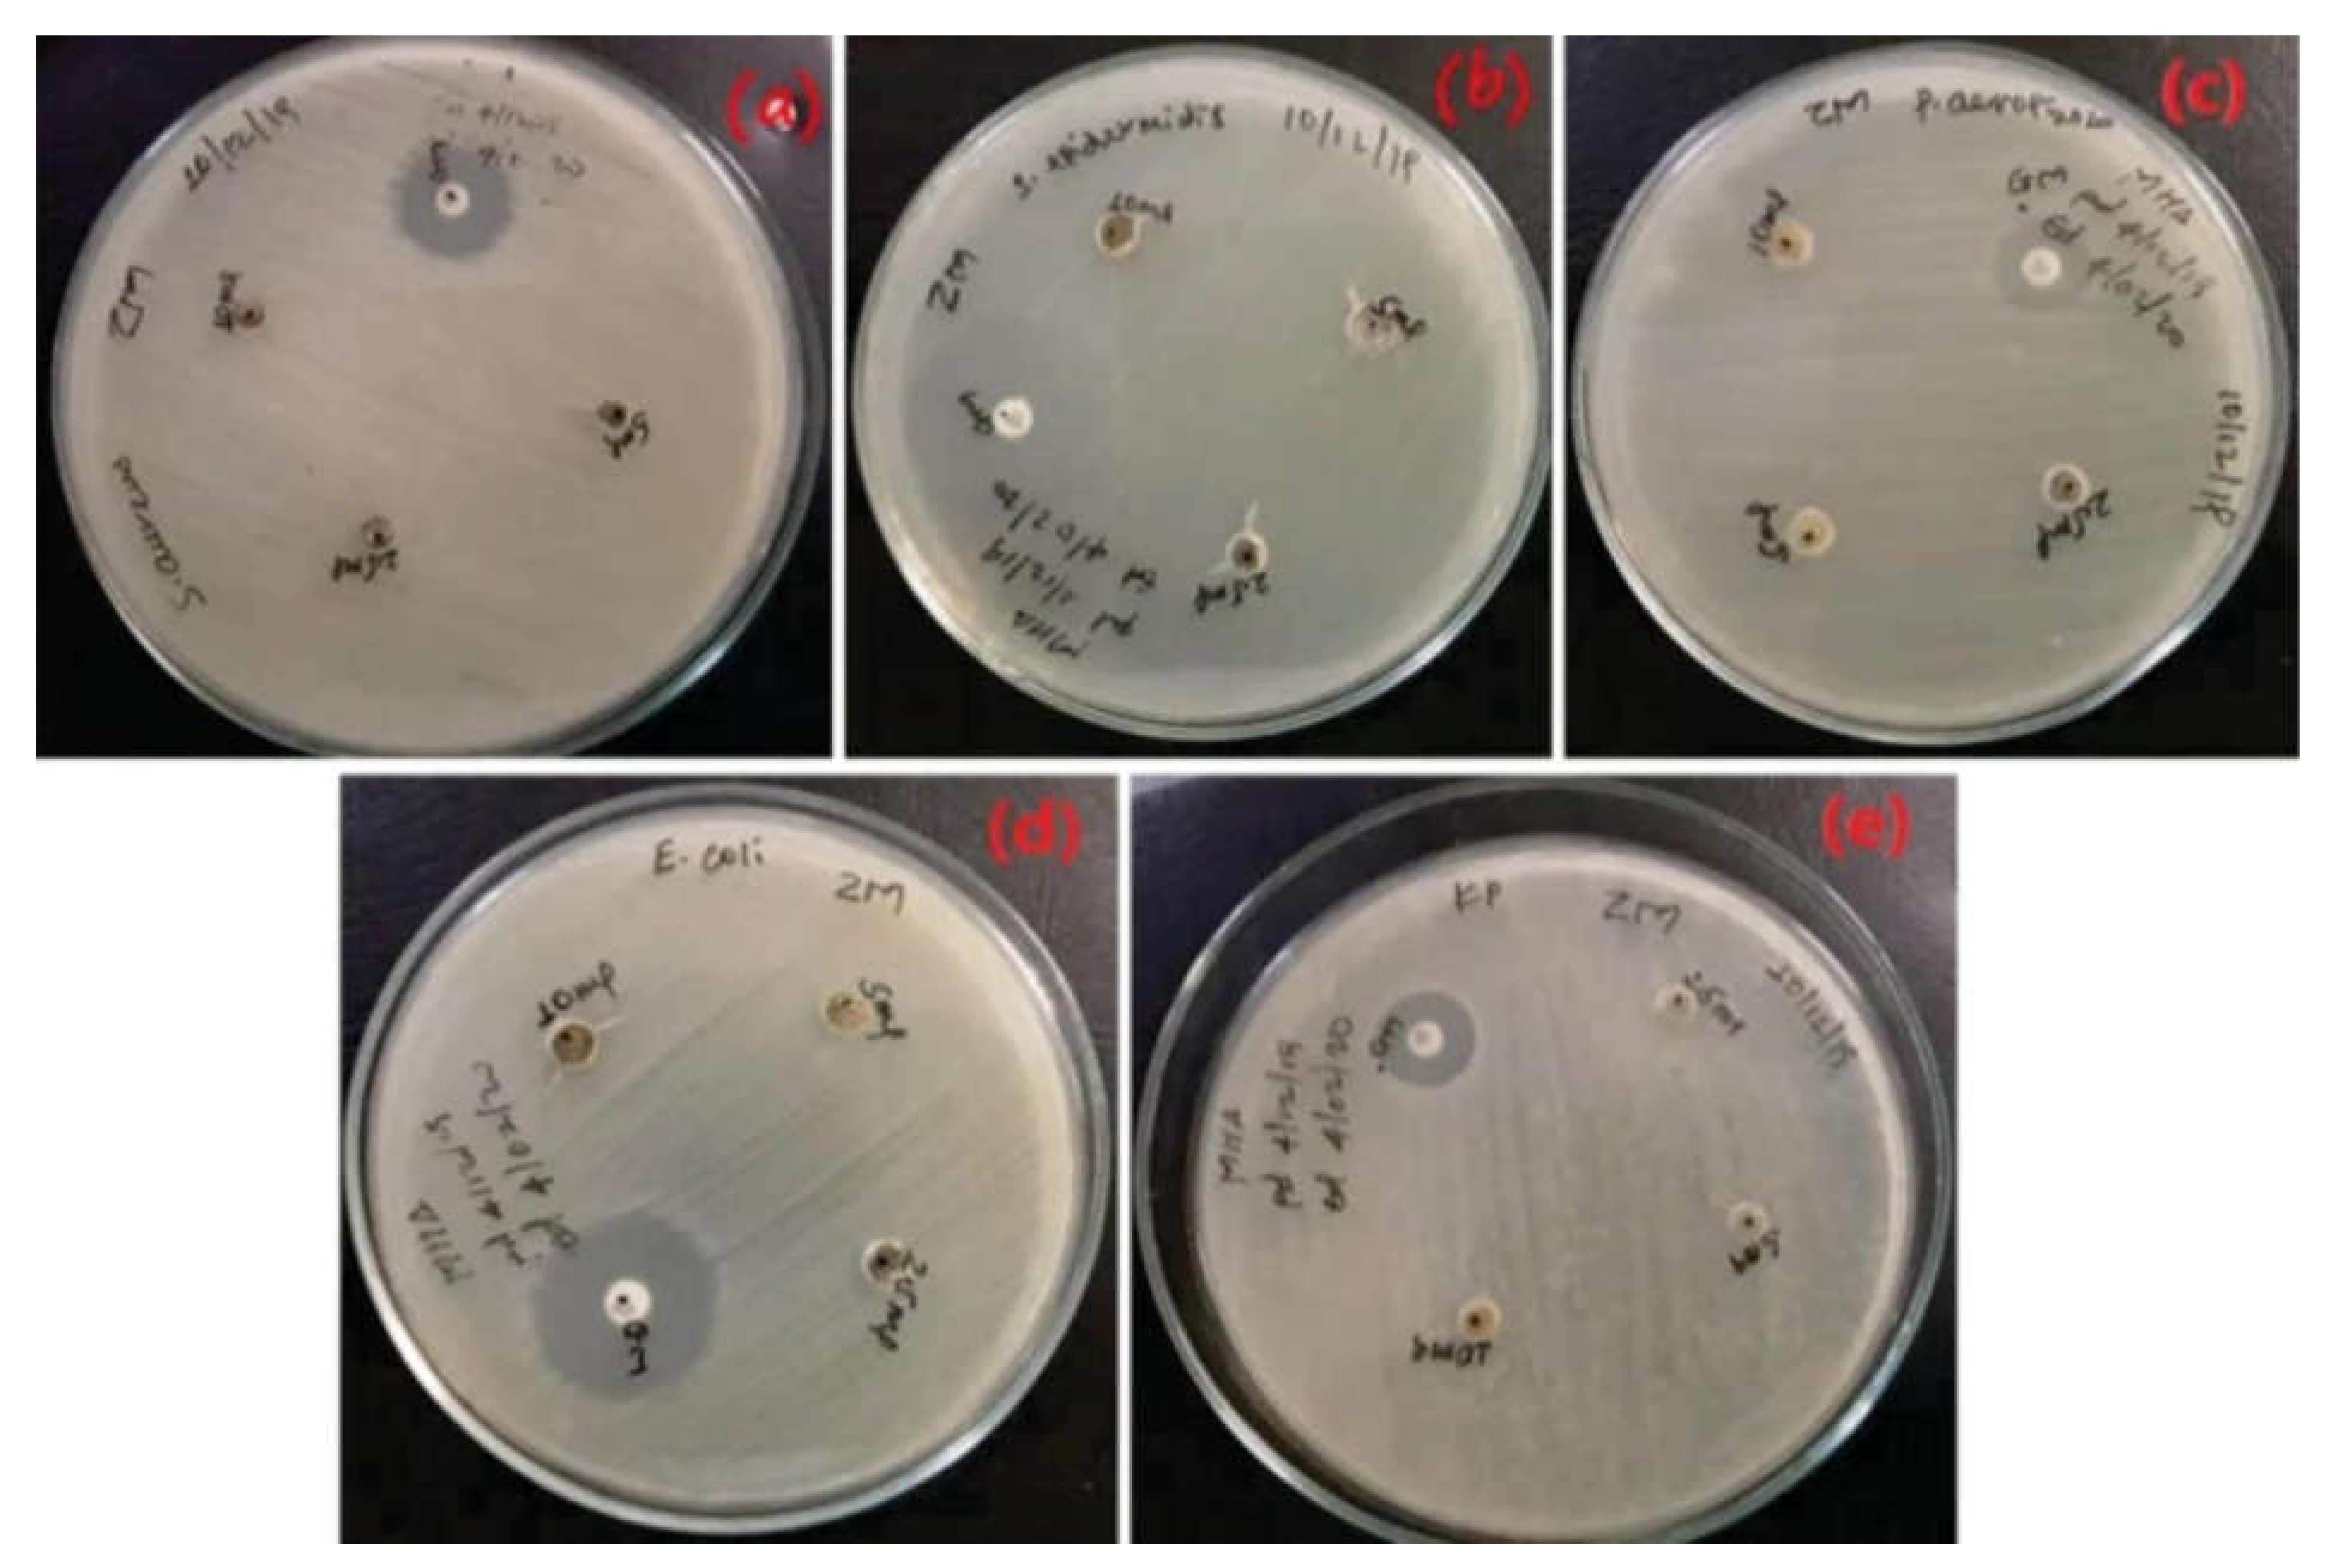
Coatings 11 01374 g003

Green Synthesis of Metal and Metal Oxide Nanoparticles Using Different Plants’ Parts for Antimicrobial Activity and Anticancer Activity: A Review Article
Abstract
:1. Introduction
2. Green Chemistry and Sustainable Principle
3. Synthesis of Metal and Metal Oxide Nanoparticles Using Plants
4. Role of Capping Agents in the Synthesis of Metal and Metal Oxide Nanoparticles
5. Role of Phytochemicals in the Synthesis of Metal and Metal Oxide Nanoparticles
5.1. Role of Amino Acid in Green Synthesis of Nanoparticles
5.2. Role of Protein in Green Synthesis of Nanoparticles
5.3. Role of Carbohydrates or Saccharides in Green Synthesis of Nanoparticles
- Low cost
- Stable
- Safe
- Nontoxic
- Hydrophilic
5.4. Role of Phenolics Acid in Green Synthesis of Nanoparticles
5.5. Role of Flavonoid in Green Synthesis of Nanoparticles
5.6. Role of Terpenoids in Green Synthesis of Nanoparticles
6. Synthesis of Metal or Metal Oxides’ Nanoparticles by Using Plants
6.1. Zinc Oxide Nanoparticles
6.1.1. Synthesis of ZnO Nanoparticles Using Leaf: (2019–2021)
6.1.2. Synthesis of ZnO Nanoparticles Using Roots and Root Hairs (2020–2021)
6.1.3. Synthesis of ZnO Nanoparticles Using Stem and Stem Bark: (2019–2021)
6.1.4. Synthesis of ZnO Nanoparticles Using Flower Extract: (2019–2021)
6.1.5. Synthesis of ZnO Nanoparticles Using Seed (2020–2019)
6.1.6. Synthesis of ZnO Nanoparticles Using Fruit and Fruit Peel: (2019–2021)
6.2. Gold Nanoparticles
6.2.1. Synthesis of Gold Nanoparticles from Plant
6.2.2. Synthesis of Gold Nanoparticles Using Leaves: (2019–2021)
6.2.3. Synthesis of Gold Nanoparticles Using Root Extracts: (2021–2019)
6.2.4. Synthesis of Gold Nanoparticles Using Stem Extracts: (2021–2019)
6.2.5. Synthesis of Gold Nanoparticles Using Flower Extracts: (2021–2019)
6.3. Silver Nanoparticles
6.3.1. Synthesis of Silver Nanoparticles
6.3.2. Synthesis of Silver Nanoparticles Using Leaf Extracts: (2019–2020)
6.3.3. Synthesis of Silver Nanoparticles Using Root Extracts: (2021–2020)
6.3.4. Synthesis of Silver Nanoparticles Using Stem and Stem Bark Extracts: (2019–2021)
6.3.5. Synthesis of Silver Nanoparticles Using Seed Extracts: (2019–2021)
6.3.6. Synthesis of Silver Nanoparticles Using Flower Extracts:(2021)
6.4. Titanium Oxide Nanoparticles
Synthesis of Titanium Oxide Nanoparticles from Leaves, Roots, Flowers, Seeds, and Fruit Peel Extracts: (2019–2021)
6.5. Copper and Copper Oxide Nanoparticles
Synthesis of Copper and Copper Oxide Nanoparticles Using Leaves, Seeds, Flower, and Fruit Peel Extracts: (2019–2021)
6.6. Iron or Iron Oxide Nanoparticles
Synthesis of Iron and Iron Oxide Nanoparticles from Leaf, Flower, Seed, and Fruit Extracts: (2019–2021)
6.7. Cobalt and Cobalt Oxide Nanoparticles
Synthesis of Cobalt or Cobalt Oxide Nanoparticles Using Plants
7. Antibacterial Activities of Metal and Metal Oxide Nanoparticles
8. Antifungal Activity
9. Anticancer Activity
10. Challenge and Future Perspectives of Plant-Mediated Metal and Metal Oxide Nanoparticles
11. Conclusions
Author Contributions
Funding
Institutional Review Board Statement
Informed Consent Statement
Data Availability Statement
Acknowledgments
Conflicts of Interest
Abbreviation
| S. aureus | Staphylococcus aureus |
| E. coli | Escherichia coli |
| B. Subtilis | Bacillus subtilis |
| P. aeruginosa | Pseudomonas aeruginosa |
| C. Albicans | Candida albicans |
| E. faecalis | Enterococcus faecalis |
| B. cereus | Bacillus cereus |
| K. Pneumoniae | Klebsiella pneumoniae |
| S. typhi | Salmonella typhi |
| P. mirabilis | Proteus mirabilis |
References
- Auffan, M.; Rose, J.; Bottero, J.-Y.; Lowry, G.V.; Jolivet, J.-P.; Wiesner, M.R. Towards a definition of inorganic nanoparticles from an environmental, health and safety perspective. Nat. Nanotechnol. 2009, 4, 634–641. [Google Scholar] [CrossRef] [PubMed]
- Narayanan, K.B.; Sakthivel, N. Biological synthesis of metal nanoparticles by microbes. Adv. Colloid Interface Sci. 2010, 156, 1–13. [Google Scholar] [CrossRef] [PubMed]
- Surendra, T.V.; Roopan, S.M.; Khan, M.R. Biogenic approach to synthesize rod shaped Gd2O3 nanoparticles and its optimization using response surface methodology-Box–Behnken design model. Biotechnol. Prog. 2019, 35, e2823. [Google Scholar] [CrossRef]
- Sabir, S.; Arshad, M.; Chaudhari, S.K. Zinc Oxide Nanoparticles for Revolutionizing Agriculture: Synthesis and Applications. Sci. World J. 2014, 2014, 1–8. [Google Scholar] [CrossRef] [Green Version]
- Ditta, A.; Arshad, M.; Ibrahim, M. Nanoparticles in Sustainable Agricultural Crop Production: Applications and Perspectives. In Nanotechnology and Plant Sciences; Springer: Cham, Switzerland, 2015; pp. 55–75. [Google Scholar] [CrossRef]
- Sukumaran, P.; Poulose, E.K. Silver nanoparticles: Mechanism of antimicrobial action, synthesis, medical applications, and toxicity effects. Int. Nano Lett. 2012, 2, 1–10. [Google Scholar]
- Lee, Y.; Choi, J.-R.; Lee, K.J.; E Stott, N.; Kim, D. Large-scale synthesis of copper nanoparticles by chemically controlled reduction for applications of inkjet-printed electronics. Nanotechnology 2008, 19, 415604. [Google Scholar] [CrossRef] [PubMed]
- Naoki, T.; Yonezawa, T. Bimetallic nanoparticles—novel materials for chemical and physical applications. New J. Chem. 1998, 22, 1179–1201. [Google Scholar]
- Reddy, L.H.; Arias, J.L.; Nicolas, J.; Couvreur, P. Magnetic Nanoparticles: Design and Characterization, Toxicity and Biocompatibility, Pharmaceutical and Biomedical Applications. Chem. Rev. 2012, 112, 5818–5878. [Google Scholar] [CrossRef] [PubMed]
- Antonyraj, C.A.; Jeong, J.; Kim, B.; Shin, S.; Kim, S.; Lee, K.-Y.; Cho, J.K. Selective oxidation of HMF to DFF using Ru/γ-alumina catalyst in moderate boiling solvents toward industrial production. J. Ind. Eng. Chem. 2012, 19, 1056–1059. [Google Scholar] [CrossRef]
- Neville, F.; A Pchelintsev, N.; Broderick, M.J.F.; Gibson, T.; A Millner, P. Novel one-pot synthesis and characterization of bioactive thiol-silicate nanoparticles for biocatalytic and biosensor applications. Nanotechnology 2009, 20, 055612. [Google Scholar] [CrossRef]
- Staniland, S.S. Magnetosomes: Bacterial biosynthesis of magnetic nanoparticles and potential biomedical applications. Nanotechnol. Life Sci. Online 2007, 2011. [Google Scholar]
- Luo, X.; Luo, X.; Morrin, A.; Killard, A.J.; Smyth, M.R. Application of nanoparticles in electrochemical sensors and biosensors. Electroanal. Int. J. Devoted Fundam. Pract. Asp. Electroanal. 2006, 18, 319–326. [Google Scholar] [CrossRef] [Green Version]
- Murthy, S.K. Nanoparticles in modern medicine: State of the art and future challenges. Int. J. Nanomed. 2007, 2, 129–141. [Google Scholar]
- Wen, Z.-Q.; Li, G.; Ren, D. Detection of Trace Melamine in Raw Materials Used for Protein Pharmaceutical Manufacturing Using Surface-Enhanced Raman Spectroscopy (SERS) with Gold Nanoparticles. Appl. Spectrosc. 2011, 65, 514–521. [Google Scholar] [CrossRef]
- Xia, Y.; Yang, H.; Campbell, C.T. Nanoparticles for catalysis. Acc. Chem. Res. 2013, 46, 1671–1672. [Google Scholar] [CrossRef]
- Cao, G.; Wang, Y. Nanostructures and Nanomaterials: Synthesis, Properties Applications; Imperial College Press: London, UK, 2004. [Google Scholar]
- Fazal-ur-Rehman, M.; Qayyum, I.; Ibrahim, M.S. Nanotechnology: An innovation in scientific research and technology. Curr. Sci. 2019, 5, 48–59. [Google Scholar]
- Tshoko, S. Spectroelectrochemical Graphene-Silver/Zinc Oxide Nanoparticulate Phenotype Biosensors for Ethambutol and Pyrazinamide. Master’s Thesis, University of the Western Cape, Cape Town, South Africa, 2019. [Google Scholar]
- El Shafey, A.M. Green synthesis of metal and metal oxide nanoparticles from plant leaf extracts and their applications: A review. Green Process. Synth. 2020, 9, 304–339. [Google Scholar] [CrossRef]
- Clark, J.H.; Macquarrie, D.J. Handbook of Green Chemistry and Technology; Wiley: Hoboken, NJ, USA, 2008. [Google Scholar]
- Robert, K.W.; Parris, T.M.; Leiserowitz, A.A. What is sustainable development? Goals, indicators, values, and practice. Environ. Sci. Policy Sustain. Dev. 2005, 47, 8–21. [Google Scholar] [CrossRef]
- Omer, A.M. Energy, environment and sustainable development. Renew. Sustain. Energy Rev. 2008, 12, 2265–2300. [Google Scholar] [CrossRef]
- Wilson, M.P.; Schwarzman, M.R. Toward a new US chemicals policy: Rebuilding the foundation to advance new science, green chemistry, and environmental health. Environ. Health Perspect. 2009, 117, 1202–1209. [Google Scholar] [CrossRef] [Green Version]
- Crowl, D.A.; Louvar, J.F. Chemical Process Safety: Fundamentals with Applications; Pearson Education: London, UK, 2001. [Google Scholar]
- Anastas, P.; Eghbali, N. Green chemistry: Principles and practice. Chem. Soc. Rev. 2010, 39, 301–312. [Google Scholar] [CrossRef]
- Centi, G.; Perathoner, S. From green to sustainable industrial chemistry. In Sustainable Industrial Chemistry; Cavani, F., Centi, G., Perathoner, S., Trifiró, F., Eds.; Wiley: Hoboken, NJ, USA, 2009. [Google Scholar]
- Al Ansari, M.S. A review of optimal designs in relation to supply chains and sustainable chemical processes. Mod. Appl. Sci. 2012, 6, 74. [Google Scholar] [CrossRef]
- Pal, G.; Rai, P.; Pandey, A. Green synthesis of nanoparticles: A greener approach for a cleaner future. In Green Synthesis, Characterization and Applications of Nanoparticles; Elsevier: Amsterdam, The Netherlands, 2019; pp. 1–26. [Google Scholar]
- Mohanpuria, P.; Rana, N.K.; Yadav, S.K. Biosynthesis of nanoparticles: Technological concepts and future applications. J. Nanoparticle Res. 2007, 10, 507–517. [Google Scholar] [CrossRef]
- Hulkoti Nasreen, I.; Taranath, T.C. Biosynthesis of nanoparticles using microbes—a review. Colloids Surf. B Biointerfaces 2014, 121, 474–483. [Google Scholar] [CrossRef]
- Iravani, S. Green synthesis of metal nanoparticles using plants. Green Chem. 2011, 13, 2638–2650. [Google Scholar] [CrossRef]
- Gittins, D.I.; Bethell, D.; Schiffrin, D.J.; Nichols, R. A nanometre-scale electronic switch consisting of a metal cluster and redox-addressable groups. Nature 2000, 408, 67–69. [Google Scholar] [CrossRef] [PubMed]
- Sumera; Anwar, A.; Ovais, M.; Khan, A.; Raza, A. Docetaxel-loaded solid lipid nanoparticles: A novel drug delivery system. IET Nanobiotechnology 2017, 11, 621–629. [Google Scholar] [CrossRef]
- Awan, U.A.; Ali, S.; Rehman, M.; Zia, N.; Naz, S.S.; Ovais, M.; Raza, A. Stable and reproducible synthesis of gold nanorods for biomedical applications: A comprehensive study. Iet Nanobiotechnology 2018, 12, 182–190. [Google Scholar] [CrossRef]
- Emmanuel, R.; Saravanan, M.; Ovais, M.; Padmavathy, S.; Shinwari, Z.K.; Prakash, P. Antimicrobial efficacy of drug blended biosynthesized colloidal gold nanoparticles from Justicia glauca against oral pathogens: A nanoantibiotic approach. Microb. Pathog. 2017, 113, 295–302. [Google Scholar] [CrossRef]
- Khalil, A.T.; Ovais, M.; Ullah, I.; Ali, M.; Shinwari, Z.K.; Khamlich, S.; Maaza, M. Sageretia thea (Osbeck.) mediated synthesis of zinc oxide nanoparticles and its biological applications. Nanomedicine 2017, 12, 1767–1789. [Google Scholar] [CrossRef]
- Mashwani, Z.-U.; Khan, M.A.; Khan, T.; Nadhman, A. Applications of plant terpenoids in the synthesis of colloidal silver nanoparticles. Adv. Colloid Interface Sci. 2016, 234, 132–141. [Google Scholar] [CrossRef]
- Mukherjee, S.; Sushma, V.; Patra, S.; Barui, A.K.; Bhadra, M.P.; Sreedhar, B.; Patra, C.R. Green chemistry approach for the synthesis and stabilization of biocompatible gold nanoparticles and their potential applications in cancer therapy. Nanotechnology 2012, 23, 455103. [Google Scholar] [CrossRef] [PubMed]
- Mukherjee, S.; Vinothkumar, B.; Prashanthi, S.; Bangal, P.R.; Sreedhar, B.; Patra, C.R. Potential therapeutic and diagnostic applications of one-step in situ biosynthesized gold nanoconjugates (2-in-1 system) in cancer treatment. RSC Adv. 2012, 3, 2318–2329. [Google Scholar] [CrossRef]
- Mukherjee, S.; Debabrata, C.; Rajesh, K.; Sujata, P. Potential theranostics application of bio-synthesized silver nanoparticles (4-in-1 system). Theranostics 2014, 4, 316. [Google Scholar] [CrossRef] [PubMed] [Green Version]
- Mukherjee, S.; Dasari, M.; Priyamvada, S.; Kotcherlakota, R.; Bollu, V.S.; Patra, C.R. A green chemistry approach for the synthesis of gold nanoconjugates that induce the inhibition of cancer cell proliferation through induction of oxidative stress and their in vivo toxicity study. J. Mater. Chem. B 2015, 3, 3820–3830. [Google Scholar] [CrossRef]
- Mukherjee, S.; Sau, S.; Madhuri, D.; Bollu, V.S.; Madhusudana, K.; Sreedhar, B.; Banerjee, R.; Patra, C.R. Green synthesis and characterization of monodispersed gold nanoparticles: Toxicity study, delivery of doxorubicin and its bio-distribution in mouse model. J. Biomed. Nanotechnol. 2016, 12, 165–181. [Google Scholar] [CrossRef] [PubMed]
- Zohra, T.; Ovais, M.; Khalil, A.T.; Qasim, M.; Ayaz, M.; Shinwari, Z.K. Extraction optimization, total phenolic, flavonoid contents, HPLC-DAD analysis and diverse pharmacological evaluations of Dysphania ambrosioides (L.) Mosyakin & Clemants. Nat. Prod. Res. 2018, 33, 136–142. [Google Scholar] [CrossRef]
- Maruyama, T.; Fujimoto, Y.; Maekawa, T. Synthesis of gold nanoparticles using various amino acids. J. Colloid Interface Sci. 2015, 447, 254–257. [Google Scholar] [CrossRef]
- Polavarapu, L.; Xu, Q.H. A single-step synthesis of gold nanochains using an amino acid as a capping agent and characterization of their optical properties. Nanotechnology 2008, 19, 075601. [Google Scholar] [CrossRef]
- Ramani, M.; Ponnusamy, S.; Muthamizhchelvan, C.; Marsili, E. Amino acid-mediated synthesis of zinc oxide nanostructures and evaluation of their facet-dependent antimicrobial activity. Colloids Surfaces B: Biointerfaces 2014, 117, 233–239. [Google Scholar] [CrossRef]
- Li, S.; Shen, Y.; Xie, A.; Yu, X.; Qiu, L.; Zhang, L.; Zhang, Q. Green synthesis of silver nanoparticles using Capsicum annuum L. extract. Green Chem. 2007, 9, 852–858. [Google Scholar] [CrossRef]
- Ashraf, S.; Abbasi, A.Z.; Pfeiffer, C.; Hussain, S.Z.; Khalid, Z.M.; Gil, P.R.; Parak, W.J.; Hussain, I. Protein-mediated synthesis, pH-induced reversible agglomeration, toxicity and cellular interaction of silver nanoparticles. Colloids Surfaces B Biointerfaces 2013, 102, 511–518. [Google Scholar] [CrossRef] [PubMed]
- Parveen, R.; Shamsi, T.N.; Fatima, S. Nanoparticles-protein interaction: Role in protein aggregation and clinical implications. Int. J. Biol. Macromol. 2016, 94, 386–395. [Google Scholar] [CrossRef] [PubMed]
- Shukla, R.; Nune, S.K.; Chanda, N.; Katti, K.; Mekapothula, S.; Kulkarni, R.R.; Welshons, W.V.; Kannan, R.; Katti, K.V. Soybeans as a phytochemical reservoir for the production and stabilization of biocompatible gold nanoparticles. Small 2008, 4, 1425–1436. [Google Scholar] [CrossRef]
- Raveendran, P.; Fu, J.; Wallen, S.L. Completely “green” synthesis and stabilization of metal nanoparticles. J. Am. Chem. Soc. 2003, 125, 13940–13941. [Google Scholar] [CrossRef]
- Zhao, X.; Xia, Y.; Li, Q.; Ma, X.; Quan, F.; Geng, C.; Han, Z. Microwave-assisted synthesis of silver nanoparticles using sodium alginate and their antibacterial activity. Colloids Surfaces A: Physicochem. Eng. Asp. 2014, 444, 180–188. [Google Scholar] [CrossRef]
- Akhlaghi, S.P.; Peng, B.; Yao, Z.; Tam, K.C. Sustainable nanomaterials derived from polysaccharides and amphiphilic compounds. Soft Matter 2013, 9, 7905–7918. [Google Scholar] [CrossRef]
- Duan, H.; Wang, D.; Li, Y. Green chemistry for nanoparticle synthesis. Chem. Soc. Rev. 2015, 44, 5778–5792. [Google Scholar] [CrossRef] [PubMed]
- Boury, B.; Plumejeau, S. Metal oxides and polysaccharides: An efficient hybrid association for materials chemistry. Green Chem. 2014, 17, 72–88. [Google Scholar] [CrossRef]
- Philip, D. Biosynthesis of Au, Ag and Au–Ag nanoparticles using edible mushroom extract. Spectrochim. Acta Part A: Mol. Biomol. Spectrosc. 2009, 73, 374–381. [Google Scholar] [CrossRef]
- Ali, M.; Khan, T.; Fatima, K.; Ali, Q.U.A.; Ovais, M.; Khalil, A.T.; Ullah, I.; Raza, A.; Shinwari, Z.K.; Idrees, M. Selected hepatoprotective herbal medicines: Evidence from ethnomedicinal applications, animal models, and possible mechanism of actions. Phytother. Res. 2018, 32, 199–215. [Google Scholar] [CrossRef] [Green Version]
- Edison, T.J.I.; Sethuraman, M.G. Instant green synthesis of silver nanoparticles using Terminalia chebula fruit extract and evaluation of their catalytic activity on reduction of methylene blue. Process. Biochem. 2012, 47, 1351–1357. [Google Scholar] [CrossRef]
- Kumar, K.M.; Mandal, B.K.; Sinha, M.; Krishnakumar, V. Terminalia chebula mediated green and rapid synthesis of gold nanoparticles. Spectrochim. Acta Part A Mol. Biomol. Spectrosc. 2012, 86, 490–494. [Google Scholar] [CrossRef]
- Winkel-Shirley, B. Flavonoid biosynthesis. A colorful model for genetics, biochemistry, cell biology, and biotechnology. Plant Physiol. 2001, 126, 485–493. [Google Scholar] [CrossRef] [PubMed] [Green Version]
- Zhou, Y.; Lin, W.; Huang, J.; Wang, W.; Gao, Y.; Lin, L.; Li, Q.; Lin, L.; Du, M. Biosynthesis of Gold Nanoparticles by Foliar Broths: Roles of Biocompounds and Other Attributes of the Extracts. Nanoscale Res. Lett. 2010, 5, 1351–1359. [Google Scholar] [CrossRef] [Green Version]
- Lee, J.; Kim, H.Y.; Zhou, H.; Hwang, S.; Koh, K.; Han, D.-W.; Lee, J. Green synthesis of phytochemical-stabilized Au nanoparticles under ambient conditions and their biocompatibility and antioxidative activity. J. Mater. Chem. 2011, 21, 13316–13326. [Google Scholar] [CrossRef]
- Mittal, A.K.; Kumar, S.; Banerjee, U.C. Quercetin and gallic acid mediated synthesis of bimetallic (silver and selenium) nanoparticles and their antitumor and antimicrobial potential. J. Colloid Interface Sci. 2014, 431, 194–199. [Google Scholar] [CrossRef] [PubMed]
- Moulton, M.C.; Braydich-Stolle, L.K.; Nadagouda, M.N.; Kunzelman, S.; Hussain, S.M.; Varma, R.S. Synthesis, characterization and biocompatibility of green” synthesized silver nanoparticles using tea polyphenols. Nanoscale 2010, 2, 763–770. [Google Scholar] [CrossRef]
- Raghunandan, D.; Basavaraja, S.; Mahesh, B.; Balaji, S.; Manjunath, S.Y.; Venkataraman, A. Biosynthesis of Stable Polyshaped Gold Nanoparticles from Microwave-Exposed Aqueous Extracellular Anti-malignant Guava (Psidium guajava) Leaf Extract. NanoBiotechnology 2009, 5, 34–41. [Google Scholar] [CrossRef]
- Ahmad, N.; Sharma, S.; Alam, K.; Singh, V.; Shamsi, S.; Mehta, B.; Fatma, A. Rapid synthesis of silver nanoparticles using dried medicinal plant of basil. Colloids Surfaces B Biointerfaces 2010, 81, 81–86. [Google Scholar] [CrossRef]
- Ghoreishi, S.M.; Behpour, M.; Khayatkashani, M. Green synthesis of silver and gold nanoparticles using Rosa damascena and its primary application in electrochemistry. Phys. E Low Dimens. Syst. Nanostructures 2011, 44, 97–104. [Google Scholar] [CrossRef]
- Singh, J.; Dutta, T.; Kim, K.H.; Rawat, M.; Samddar, P.; Kumar, P. ‘Green’synthesis of metals and their oxide nanoparticles: Applications for environmental remediation. J. Nanobiotechnol. 2018, 16, 1–24. [Google Scholar] [CrossRef]
- Vilas, V.; Philip, D.; Mathew, J. Catalytically and biologically active silver nanoparticles synthesized using essential oil. Spectrochim. Acta Part A Mol. Biomol. Spectrosc. 2014, 132, 743–750. [Google Scholar] [CrossRef]
- Song, J.Y.; Kim, B.S. Rapid biological synthesis of silver nanoparticles using plant leaf extracts. Bioprocess Biosyst. Eng. 2009, 32, 79–84. [Google Scholar] [CrossRef]
- Kumari, M.M.; Philip, D. Facile one-pot synthesis of gold and silver nanocatalysts using edible coconut oil. Spectrochim. Acta Part A Mol. Biomol. Spectrosc. 2013, 111, 154–160. [Google Scholar] [CrossRef] [PubMed]
- González-Rivera, J.; Duce, C.; Ierardi, V.; Longo, I.; Spepi, A.; Tiné, M.R.; Ferrari, C. Fast and Eco-friendly Microwave-Assisted Synthesis of Silver Nanoparticles using Rosemary Essential Oil as Renewable Reducing Agent. ChemistrySelect 2017, 2, 2131–2138. [Google Scholar] [CrossRef]
- Da Silva, E.C.; Da Silva, M.G.A.; Meneghetti, S.M.P.; Machado, G.; Alencar, M.A.R.C.; Hickmann, J.M.; Meneghetti, M.R. Synthesis of colloids based on g.old nanoparticles dispersed in castor oil. J. Nanoparticle Res. 2008, 10, 201–208. [Google Scholar] [CrossRef]
- Sheny, D.; Mathew, J.; Philip, D. Synthesis characterization and catalytic action of hexagonal gold nanoparticles using essential oils extracted from Anacardium occidentale. Spectrochim. Acta Part A: Mol. Biomol. Spectrosc. 2012, 97, 306–310. [Google Scholar] [CrossRef]
- Jiang, J.; Pi, J.; Cai, J. The Advancing of Zinc Oxide Nanoparticles for Biomedical Applications. Bioinorg. Chem. Appl. 2018, 2018, 1–18. [Google Scholar] [CrossRef] [PubMed]
- Rajeshkumar, S.; Kumar, S.V.; Ramaiah, A.; Agarwal, H.; Lakshmi, T.; Roopan, S.M. Biosynthesis of zinc oxide nanoparticles using Mangifera indica leaves and evaluation of their antioxidant and cytotoxic properties in lung cancer (A549) cells. Enzym. Microb. Technol. 2018, 117, 91–95. [Google Scholar] [CrossRef] [PubMed]
- Madhumitha, G.; Elango, G.; Roopan, S.M. Biotechnological aspects of ZnO nanoparticles: Overview on synthesis and its applications. Appl. Microbiol. Biotechnol. 2015, 100, 571–581. [Google Scholar] [CrossRef]
- Saemi, R.; Taghavi, E.; Jafarizadeh-Malmiri, H.; Anarjan, N. Fabrication of green ZnO nanoparticles using walnut leaf extract to develop an antibacterial film based on polyethylene–starch–ZnO NPs. Green Process. Synth. 2021, 10, 112–124. [Google Scholar] [CrossRef]
- Demissie, M.G.; Sabir, F.K.; Edossa, G.D.; Gonfa, B.A. Synthesis of zinc oxide nanoparticles using leaf extract of lippiaadoensis (koseret) and evaluation of its antibacterial activity. J. Chem. 2020, 2020, 7459042. [Google Scholar] [CrossRef]
- Jayachandran, A.; Aswathy, T.R.; Nair, A.S. Green synthesis and characterization of zinc oxide nanoparticles using Cayratiapedata leaf extract. Biochem. Biophys. Rep. 2021, 26, 100995. [Google Scholar]
- Thi Tran, Q.M.; Thi Nguyen, H.A.; Doan, V.D.; Tran, Q.H.; Nguyen, V.C. Biosynthesis of Zinc Oxide Nanoparticles Using Aqueous Piper betle Leaf Extract and Its Application in Surgical Sutures. J. Nanomater. 2021, 2021, 8833864. [Google Scholar] [CrossRef]
- Hagos, K.M. Synthesis and characterization of ZnO nanoparticles using aqueous extract of Becium grandiflorum for antimicrobial activity and adsorption of methylene blue. Appl. Water Sci. 2021, 11, 1–12. [Google Scholar]
- Saeed, S.; Nawaz, S.; Nisar, A.; Mehmood, T.; Tayyab, M.; Nawaz, M.; Firyal, S.; Bilal, M.; Mohyuddin, A.; Ullah, A. Effective fabrication of zinc-oxide (ZnO) nanoparticles using Achyranthes aspera leaf extract and their potent biological activities against the bacterial poultry pathogens. Mater. Res. Express 2021, 8, 035004. [Google Scholar] [CrossRef]
- El-Belely, E.F.; Farag, M.; Said, H.A.; Amin, A.S.; Azab, E.; Gobouri, A.A.; Fouda, A. Green synthesis of zinc oxide nanoparticles (ZnO-NPs) using Arthrospira platensis (Class: Cyanophyceae) and evaluation of their biomedical activities. Nanomaterials 2021, 11, 95. [Google Scholar] [CrossRef] [PubMed]
- Alamdari, S.; Ghamsari, M.S.; Lee, C.; Han, W.; Park, H.-H.; Tafreshi, M.J.; Afarideh, H.; Ara, M.H.M. Preparation and Characterization of Zinc Oxide Nanoparticles Using Leaf Extract of Sambucus ebulus. Appl. Sci. 2020, 10, 3620. [Google Scholar] [CrossRef]
- Droepenu, E.K.; Asare, E.A.; Wee, B.S.; Wahi, R.B.; Ayertey, F.; Kyene, M.O. Biosynthesis, characterization, and antibacterial activity of ZnO nanoaggregates using aqueous extract from Anacardium occidentale leaf: Comparative study of different precursors. Beni Suef Univ. J. Basic Appl. Sci. 2021, 10, 1–10. [Google Scholar] [CrossRef]
- Barzinjy, A.A.; Azeez, H.H. Green synthesis and characterization of zinc oxide nanoparticles using Eucalyptus globulus Labill. leaf extract and zinc nitrate hexahydrate salt. SN Appl. Sci. 2020, 2, 1–14. [Google Scholar] [CrossRef]
- Naseer, M.; Aslam, U.; Khalid, B.; Chen, B. Green route to synthesize Zinc Oxide Nanoparticles using leaf extracts of Cassia fistula and Melia azadarach and their antibacterial potential. Sci. Rep. 2020, 10, 1–10. [Google Scholar] [CrossRef] [PubMed]
- Ahmad, W.; Kalra, D. Green synthesis, characterization and anti microbial activities of ZnO nanoparticles using Euphorbia hirta leaf extract. J. King Saud Univ. Sci. 2020, 32, 2358–2364. [Google Scholar] [CrossRef]
- Rahaiee, S.; Ranjbar, M.; Azizi, H.; Govahi, M.; Zare, M. Green synthesis, characterization, and biological activities of saffron leaf extract-mediated zinc oxide nanoparticles: A sustainable approach to reuse an agricultural waste. Appl. Organomet. Chem. 2020, 34, e5705. [Google Scholar] [CrossRef]
- Rahaiee, S.; Ranjbar, M.; Azizi, H.; Govahi, M.; Zare, M. Synthesis of ZnO nanoparticles by two different methods comparison of their structural, antibacterial, photocatalytic and optical properties. Nano Express 2020, 1, 010007. [Google Scholar]
- Jan, H.; Shah, M.; Usman, H.; Khan, A.; Muhammad, Z.; Hano, C.; Abbasi, B.H. Biogenic synthesis and characterization of antimicrobial and anti-parasitic zinc oxide (ZnO) nanoparticles using aqueous extracts of the Himalayan columbine (Aquilegia pubiflora). Front. Mater. 2020, 7, 249. [Google Scholar] [CrossRef]
- Osuntokun, J.; Onwudiwe, D.C.; Ebenso, E.E. Green synthesis of ZnO nanoparticles using aqueous Brassica oleracea L. var. italica and the photocatalytic activity. Green Chem. Lett. Rev. 2019, 12, 444–457. [Google Scholar] [CrossRef] [Green Version]
- Vinotha, V.; Iswarya, A.; Thaya, R.; Govindarajan, M.; Alharbi, N.S.; Kadaikunnan, S.; Khaled, J.M.; Al-Anbr, M.N.; Vaseeharan, B. Synthesis of ZnO nanoparticles using insulin-rich leaf extract: Anti-diabetic, antibiofilm and anti-oxidant properties. J. Photochem. Photobiol. B Biol. 2019, 197, 111541. [Google Scholar] [CrossRef]
- Hussain, A.; Oves, M.; Alajmi, M.F.; Hussain, I.; Amir, S.; Ahmed, J.; Rehman, T.; El-Seedi, H.R.; Ali, I. Biogenesis of ZnO nanoparticles using Pandanus odorifer leaf extract: Anticancer and antimicrobial activities. RSC Adv. 2019, 9, 15357–15369. [Google Scholar] [CrossRef] [Green Version]
- Ezealisiji, K.M.; Siwe-Noundou, X.; Maduelosi, B.; Nwachukwu, N.; Krause, R.W.M. Green synthesis of zinc oxide nanoparticles using Solanum torvum (L) leaf extract and evaluation of the toxicological profile of the ZnO nanoparticles–hydrogel composite in Wistar albino rats. Int. Nano Lett. 2019, 9, 99–107. [Google Scholar] [CrossRef] [Green Version]
- Rajendran, N.; George, B.; Houreld, N.; Abrahamse, H. Synthesis of Zinc Oxide Nanoparticles Using Rubus fairholmianus Root Extract and Their Activity against Pathogenic Bacteria. Molecules 2021, 26, 3029. [Google Scholar] [CrossRef]
- Naser, R.; Abu-Huwaij, R.; Al-Khateeb, I.; Abbas, M.M.; Atoom, A.M. Green synthesis of zinc oxide nanoparticles using the root hair extract of Phoenix dactylifera: Antimicrobial and anticancer activity. Appl. Nanosci. 2021, 11, 1747–1757. [Google Scholar] [CrossRef]
- Liu, D.; Liu, L.; Yao, L.; Peng, X.; Li, Y.; Jiang, T.; Kuang, H. Synthesis of ZnO nanoparticles using radish root extract for effective wound dressing agents for diabetic foot ulcers in nursing care. J. Drug Deliv. Sci. Technol. 2019, 55, 101364. [Google Scholar] [CrossRef]
- Shaik, A.M.; David Raju, M.; Rama Sekhara Reddy, D. Green synthesis of zinc oxide nanoparticles using aqueous root extract of Sphagneticolatrilobata Lin and investigate its role in toxic metal removal, sowing germination and fostering of plant growth. Inorg. Nano Met. Chem. 2020, 50, 569–579. [Google Scholar] [CrossRef]
- Espenti, C.S.; Krishna, A.G.R.; Reddy, Y.V.R. Green biosynthesis of ZnO nanomaterials and their anti-bacterial activity by using Moringa Oleifera root aqueous extract. SN Appl. Sci. 2020, 2, 1–11. [Google Scholar] [CrossRef]
- Jobie, F.N.; Ranjbar, M.; Moghaddam, A.H.; Kiani, M. Green synthesis of zinc oxide nanoparticles using Amygdalus scoparia Spach stem bark extract and their applications as an alternative antimicrobial, anticancer, and anti-diabetic agent. Adv. Powder Technol. 2021, 32, 2043–2052. [Google Scholar] [CrossRef]
- Ansari, M.A.; Murali, M.; Prasad, D.; Alzohairy, M.A.; Almatroudi, A.; Alomary, M.N.; Udayashankar, A.C.; Singh, S.B.; Asiri, S.M.M.; Ashwini, B.S.; et al. Cinnamomum verum Bark Extract Mediated Green Synthesis of ZnO Nanoparticles and Their Antibacterial Potentiality. Biomolecules 2020, 10, 336. [Google Scholar] [CrossRef] [PubMed] [Green Version]
- Jayappa, M.D.; Ramaiah, C.K.; Kumar, M.A.P.; Suresh, D.; Prabhu, A.; Devasya, R.P.; Sheikh, S. Green synthesis of zinc oxide nanoparticles from the leaf, stem and in vitro grown callus of Mussaendafrondosa L.: Characterization and their applications. Appl. Nanosci. 2020, 10, 3057–3074. [Google Scholar] [CrossRef]
- Umar, H.; Kavaz, D.; Rizaner, N. Biosynthesis of zinc oxide nanoparticles using Albizia lebbeck stem bark, and evaluation of its antimicrobial, antioxidant, and cytotoxic activities on human breast cancer cell lines. Int. J. Nanomed. 2019, 14, 87. [Google Scholar] [CrossRef] [PubMed] [Green Version]
- Seshadri, V.D. Zinc oxide nanoparticles from Cassia auriculata flowers showed the potent antimicrobial and in vitro anticancer activity against the osteosarcoma MG-63 cells. Saudi J. Biol. Sci. 2021, 28, 4046–4054. [Google Scholar] [CrossRef]
- Ifeanyichukwu, U.L.; Fayemi, O.E.; Ateba, C.N. Green Synthesis of Zinc Oxide Nanoparticles from Pomegranate (Punica granatum) Extracts and Characterization of Their Antibacterial Activity. Molecules 2020, 25, 4521. [Google Scholar] [CrossRef]
- Ngom, I.; Ngom, B.; Sackey, J.; Khamlich, S. Biosynthesis of zinc oxide nanoparticles using extracts of Moringa Oleifera: Structural & optical properties. Mater. Today Proc. 2020, 36, 526–533. [Google Scholar]
- Ogunyemi, S.O.; Abdallah, Y.; Zhang, M.; Fouad, H.; Hong, X.; Ibrahim, E.; Masum, M.M.I.; Hossain, A.; Mo, J.; Li, B. Green synthesis of zinc oxide nanoparticles using different plant extracts and their antibacterial activity against Xanthomonas oryzaepv. oryzae. Artif. Cells Nanomed. Biotechnol. 2019, 47, 341–352. [Google Scholar] [CrossRef] [PubMed] [Green Version]
- Lakshmeesha, T.R.; Kalagatur, N.K.; Mudili, V.; Mohan, C.D.; Rangappa, S.; Prasad, B.D.; Ashwini, B.S.; Hashem, A.; Alqarawi, A.A.; Malik, J.A.; et al. Biofabrication of zinc oxide nanoparticles with Syzygiumaromaticum flower buds extract and finding its novel application in controlling the growth and mycotoxins of Fusarium graminearum. Front. Microbiol. 2019, 10, 1244. [Google Scholar] [CrossRef] [PubMed] [Green Version]
- Umavathi, S.; Mahboob, S.; Govindarajan, M.; Al-Ghanim, K.A.; Ahmed, Z.; Virik, P.; Al-Mulhm, N.; Subash, M.; Gopinath, K.; Kavitha, C. Green synthesis of ZnO nanoparticles for antimicrobial and vegetative growth applications: A novel approach for advancing efficient high quality health care to human wellbeing. Saudi J. Biol. Sci. 2020, 28, 1808–1815. [Google Scholar] [CrossRef] [PubMed]
- Rawashdeh, R.Y.; Harb, A.M.; AlHasan, A.M. Biological interaction levels of zinc oxide nanoparticles; lettuce seeds as case study. Heliyon 2020, 6, e03983. [Google Scholar] [CrossRef]
- Shabaani, M.; Rahaiee, S.; Zare, M.; Jafari, S.M. Green synthesis of ZnO nanoparticles using loquat seed extract; Biological functions and photocatalytic degradation properties. LWT 2020, 134, 110133. [Google Scholar] [CrossRef]
- Chankaew, C.; Tapala, W.; Grudpan, K.; Rujiwatra, A. Microwave synthesis of ZnO nanoparticles using longan seeds biowaste and their efficiencies in photocatalytic decolorization of organic dyes. Environ. Sci. Pollut. Res. 2019, 26, 17548–17554. [Google Scholar] [CrossRef]
- Alshehri, A.A.; Malik, M.A. Biogenic fabrication of ZnO nanoparticles using Trigonella foenum-graecum (Fenugreek) for proficient photocatalytic degradation of methylene blue under UV irradiation. J. Mater. Sci. Mater. Electron. 2019, 30, 16156–16173. [Google Scholar] [CrossRef]
- Khan, M.; Ware, P.; Shimpi, N. Synthesis of ZnO nanoparticles using peels of Passiflora foetida and study of its activity as an efficient catalyst for the degradation of hazardous organic dye. SN Appl. Sci. 2021, 3, 1–17. [Google Scholar] [CrossRef]
- Faisal, S.; Jan, H.; Shah, S.A.; Shah, S.; Khan, A.; Akbar, M.T.; Rizwan, M.; Jan, F.; Wajidullah; Akhtar, N.; et al. Green Synthesis of Zinc Oxide (ZnO) Nanoparticles Using Aqueous Fruit Extracts of Myristica fragrans: Their Characterizations and Biological and Environmental Applications. ACS Omega 2021, 6, 9709–9722. [Google Scholar] [CrossRef]
- Gao, Y.; Xu, D.; Ren, D.; Zeng, K.; Wu, X. Green synthesis of zinc oxide nanoparticles using Citrus sinensis peel extract and application to strawberry preservation: A comparison study. LWT 2020, 126, 109297. [Google Scholar] [CrossRef]
- Thi, T.U.D.; Nguyen, T.T.; Thi, Y.D.; Thi, K.H.T.; Phan, B.T.; Pham, K.N. Green synthesis of ZnO nanoparticles using orange fruit peel extract for antibacterial activities. RSC Adv. 2020, 10, 23899–23907. [Google Scholar] [CrossRef]
- Awwad, A.M.; Amer, M.W.; Salem, N.M.; Abdeen, A.O. Green synthesis of zinc oxide nanoparticles (ZnO-NPs) using Ailanthus altissima fruit extracts and antibacterial activity. Chem. Int. 2020, 6, 151–159. [Google Scholar]
- Grace, A.N.; Pandian, K. Antibacterial efficacy of aminoglycosidic antibiotics protected gold nanoparticles—A brief study. Colloids Surf. A Physicochem. Eng. Asp. 2007, 297, 63–70. [Google Scholar] [CrossRef]
- Drechsler, U.; Erdogan, B.; Rotello, V.M. Nanoparticles: Scaffolds for Molecular Recognition. Chem. A Eur. J. 2004, 10, 5570–5579. [Google Scholar] [CrossRef]
- Lee, J.-S. Recent progress in gold nanoparticle-based non-volatile memory devices. Gold Bull. 2010, 43, 189–199. [Google Scholar] [CrossRef] [Green Version]
- van der Molen, S.J.; Liao, J.; Kudernac, T.; Agustsson, J.S.; Bernard, L.; Calame, M.; van Wees, B.J.; Feringa, B.L.; Schoönenberger, C. Light-controlled conductance switching of ordered metal-molecule-metal devices. Nano Lett. 2009, 9, 76–80. [Google Scholar] [CrossRef]
- Mackowski, S. Hybrid nanostructures for efficient light harvesting. J. Physics Condens. Matter 2010, 22, 193102. [Google Scholar] [CrossRef]
- Khan, A.; Rashid, R.; Murtaza, G.; Zahra, A. Gold Nanoparticles: Synthesis and Applications in Drug Delivery. Trop. J. Pharm. Res. 2014, 13, 1169. [Google Scholar] [CrossRef]
- Rocha-Rocha, O.; Cortez-Valadez, M.; Calderón-Ayala, G.; Martínez-Nuñez, C.; Pedroza-Montero, M.; Flores-Acosta, M. Confined clustering of AuCu nanoparticles under ambient conditions. Phys. Lett. A 2019, 383, 125985. [Google Scholar] [CrossRef]
- Aminabad, N.S.; Farshbaf, M.; Akbarzadeh, A. Recent Advances of Gold Nanoparticles in Biomedical Applications: State of the Art. Cell Biophys. 2018, 77, 123–137. [Google Scholar] [CrossRef]
- Hu, X.; Zhang, Y.; Ding, T.; Liu, J.; Zhao, H. Multifunctional Gold Nanoparticles: A Novel Nanomaterial for Various Medical Applications and Biological Activities. Front. Bioeng. Biotechnol. 2020, 8, 990. [Google Scholar] [CrossRef] [PubMed]
- Jiang, P.; Wang, Y.; Zhao, L.; Ji, C.; Chen, D.; Nie, L. Applications of Gold Nanoparticles in Non-Optical Biosensors. Nanomaterials 2018, 8, 977. [Google Scholar] [CrossRef] [PubMed] [Green Version]
- Madkour, L.H. Applications of gold nanoparticles in medicine and therapy. Pharm. Pharmacol. Int. J. 2018, 6, 1. [Google Scholar] [CrossRef] [Green Version]
- Nadeem, M.; Abbasi, B.H.; Younas, M.; Ahmad, W.; Khan, T. A review of the green syntheses and anti-microbial applications of gold nanoparticles. Green Chem. Lett. Rev. 2017, 10, 216–227. [Google Scholar] [CrossRef] [Green Version]
- Guliani, A.; Kumari, A.; Acharya, A. Green synthesis of gold nanoparticles using aqueous leaf extract of Populus alba: Characterization, antibacterial and dye degradation activity. Int. J. Environ. Sci. Technol. 2021, 6, 1–12. [Google Scholar]
- Le, V.T.; Ngu, N.N.Q.; Chau, T.P.; Nguyen, T.D.; Nguyen, V.T.; Nguyen, T.L.H.; Cao, X.T.; Doan, V.D. Silver and Gold Nanoparticles from Limnophila rugosa Leaves: Biosynthesis, Characterization, and Catalytic Activity in Reduction of Nitrophenols. J. Nanomater. 2021, 2021, 5571663. [Google Scholar] [CrossRef]
- Olajire, A.; Mohammed, A. Bio-directed synthesis of gold nanoparticles using Ananas comosus aqueous leaf extract and their photocatalytic activity for LDPE degradation. Adv. Powder Technol. 2021, 32, 600–610. [Google Scholar] [CrossRef]
- El-Borady, O.M.; Fawzy, M.; Hosny, M. Antioxidant, anticancer and enhanced photocatalytic potentials of gold nanoparticles biosynthesized by common reed leaf extract. Appl. Nanosci. 2021, 3, 1–12. [Google Scholar]
- Li, S.; Al-Misned, F.A.; El-Serehy, H.A.; Yang, L. Green synthesis of gold nanoparticles using aqueous extract of Mentha Longifolia leaf and investigation of its anti-human breast carcinoma properties in the in vitro condition. Arab. J. Chem. 2020, 14, 102931. [Google Scholar] [CrossRef]
- Shah, S.; Shah, S.A.; Faisal, S.; Khan, A.; Ullah, R.; Ali, N.; Bilal, M. Engineering novel gold nanoparticles using Sageretiathea leaf extract and evaluation of their biological activities. J. Nanostruct. Chem. 2021, 1–12. [Google Scholar]
- Jiao, Y.; Wang, X.; Chen, J.-H. Biofabrication of AuNPs using Coriandrum sativum leaf extract and their antioxidant, analgesic activity. Sci. Total. Environ. 2021, 767, 144914. [Google Scholar] [CrossRef]
- Hosny, M.; Fawzy, M. Instantaneous phytosynthesis of gold nanoparticles via Persicaria salicifolia leaf extract, and their medical applications. Adv. Powder Technol. 2021, 8, 2891–2904. [Google Scholar] [CrossRef]
- Chen, J.; Li, Y.; Fang, G.; Cao, Z.; Shang, Y.; Alfarraj, S.; Alharbi, S.A.; Li, J.; Yang, S.; Duan, X. Green synthesis, characterization, cytotoxicity, antioxidant, and anti-human ovarian cancer activities of Curcumae kwangsiensis leaf aqueous extract green-synthesized gold nanoparticles. Arab. J. Chem. 2021, 14, 103000. [Google Scholar] [CrossRef]
- Abdoli, M.; Arkan, E.; Shekarbeygi, Z.; Khaledian, S. Green synthesis of gold nanoparticles using Centaurea behen leaf aqueous extract and investigating their antioxidant and cytotoxic effects on acute leukemia cancer cell line (THP-1). Inorg. Chem. Commun. 2021, 129, 108649. [Google Scholar] [CrossRef]
- Padalia, H.; Chanda, S. Antioxidant and Anticancer Activities of Gold Nanoparticles Synthesized Using Aqueous Leaf Extract of Ziziphus nummularia. BioNanoScience 2021, 11, 281–294. [Google Scholar] [CrossRef]
- Balasubramanian, S.; Kala, S.M.J.; Pushparaj, T.L. Biogenic synthesis of gold nanoparticles using Jasminum auriculatum leaf extract and their catalytic, antimicrobial and anticancer activities. J. Drug Deliv. Sci. Technol. 2020, 57, 101620. [Google Scholar] [CrossRef]
- Sunayana, N.; Uzma, M.; Dhanwini, R.P.; Govindappa, M.; Prakash, H.S.; Raghavendra, B.V. Green Synthesis of Gold Nanoparticles from Vitex negundo Leaf Extract to Inhibit Lipopolysaccharide-Induced Inflammation Through In Vitro and In Vivo. J. Clust. Sci. 2019, 31, 463–477. [Google Scholar] [CrossRef]
- Khatua, A.; Priyadarshini, E.; Rajamani, P.; Patel, A.; Kumar, J.; Naik, A.; Saravanan, M.; Barabadi, H.; Prasad, A.; Ghosh, L.; et al. Phytosynthesis, Characterization and Fungicidal Potential of Emerging Gold Nanoparticles Using Pongamia pinnata Leave Extract: A Novel Approach in Nanoparticle Synthesis. J. Clust. Sci. 2019, 31, 125–131. [Google Scholar] [CrossRef]
- Vo, T.-T.; Dang, C.-H.; Doan, V.-D.; Dang, V.-S.; Nguyen, T.-D. Biogenic Synthesis of Silver and Gold Nanoparticles from Lactuca indica Leaf Extract and Their Application in Catalytic Degradation of Toxic Compounds. J. Inorg. Organomet. Polym. Mater. 2019, 30, 388–399. [Google Scholar] [CrossRef]
- Kumar, P.V.; Kala, S.M.J.; Prakash, K. Green synthesis of gold nanoparticles using Croton Caudatus Geisel leaf extract and their biological studies. Mater. Lett. 2018, 236, 19–22. [Google Scholar] [CrossRef]
- Kumar, I.; Mondal, M.; Meyappan, V.; Sakthivel, N. Green one-pot synthesis of gold nanoparticles using Sansevieria roxburghiana leaf extract for the catalytic degradation of toxic organic pollutants. Mater. Res. Bull. 2019, 117, 18–27. [Google Scholar] [CrossRef]
- Thangamani, N.; Bhuvaneshwari, N. Green synthesis of gold nanoparticles using Simarouba glauca leaf extract and their biological activity of micro-organism. Chem. Phys. Lett. 2019, 732, 136587. [Google Scholar] [CrossRef]
- Khoshnamvand, M.; Ashtiani, S.; Huo, C.; Saeb, S.P.; Liu, J. Use of Alcea rosea leaf extract for biomimetic synthesis of gold nanoparticles with innate free radical scavenging and catalytic activities. J. Mol. Struct. 2018, 1179, 749–755. [Google Scholar] [CrossRef]
- Vijayan, R.; Joseph, S.; Mathew, B. Anticancer, antimicrobial, antioxidant, and catalytic activities of green-synthesized silver and gold nanoparticles using Bauhinia purpurea leaf extract. Bioprocess Biosyst. Eng. 2018, 42, 305–319. [Google Scholar] [CrossRef] [PubMed]
- Boomi, P.; Ganesan, R.; Poorani, G.; Prabu, H.G.; Ravikumar, S.; Jeyakanthan, J. Biological synergy of greener gold nanoparticles by using Coleus aromaticus leaf extract. Mater. Sci. Eng. C 2019, 99, 202–210. [Google Scholar] [CrossRef] [PubMed]
- Al-Radadi, N.S. Facile one-step green synthesis of gold nanoparticles (AuNp) using licorice root extract: Antimicrobial and anticancer study against HepG2 cell line. Arab. J. Chem. 2020, 14, 102956. [Google Scholar] [CrossRef]
- Hosny, M.; Fawzy, M.; El-Borady, O.M.; Mahmoud, A.E.D. Comparative study between Phragmites australis root and rhizome extracts for mediating gold nanoparticles synthesis and their medical and environmental applications. Adv. Powder Technol. 2021, 32, 2268–2279. [Google Scholar] [CrossRef]
- Doan, V.D.; Huynh, B.A.; Nguyen, T.D.; Cao, X.T.; Nguyen, V.C.; Nguyen, T.L.H.; Nguyen, H.T.; Le, V.T. Biosynthesis of silver and gold nanoparticles using aqueous extract of Codonopsispilosula roots for antibacterial and catalytic applications. J. Nanomater. 2020, 2020, 8492016. [Google Scholar] [CrossRef]
- Zhang, T.; Dang, M.; Zhang, W.; Lin, X. Gold nanoparticles synthesized from Euphorbia fischeriana root by green route method alleviates the isoprenaline hydrochloride induced myocardial infarction in rats. J. Photochem. Photobiol. B Biol. 2019, 202, 111705. [Google Scholar] [CrossRef] [PubMed]
- Xue, J.; Liu, T.; Liu, Y.; Jiang, Y.; Seshadri, V.; Mohan, S.K.; Ling, L. Neuroprotective effect of biosynthesised gold nanoparticles synthesised from root extract of Paeonia moutan against Parkinson disease—In vitro & In vivo model. J. Photochem. Photobiol. B Biol. 2019, 200, 111635. [Google Scholar] [CrossRef]
- González-Ballesteros, N.; Vidal-González, J.; Rodríguez-Argüelles, M.C. Wealth from by-products: An attempt to synthesize valuable gold nanoparticles from Brassica oleracea var. acephala cv. Galega stems. J. Nanostructure Chem. 2021, 1–10. [Google Scholar] [CrossRef]
- Khoshnamvand, M.; Hao, Z.; Huo, C.; Liu, J. Photocatalytic degradation of 4-nitrophenol pollutant and in vitro antioxidant assay of gold nanoparticles synthesized from Apium graveolens leaf and stem extracts. Int. J. Environ. Sci. Technol. 2020, 17, 2433–2442. [Google Scholar] [CrossRef]
- Chokkalingam, M.; Rupa, E.J.; Huo, Y.; Mathiyalagan, R.; Anandapadmanaban, G.; Ahn, J.C.; Park, J.K.; Lu, J.; Yang, D.C. Photocatalytic degradation of industrial dyes using Ag and Au nanoparticles synthesized from Angelica gigas ribbed stem extracts. Optik 2019, 185, 1213–1219. [Google Scholar] [CrossRef]
- Alhumaydhi, F.A.; Khan, I.; Rauf, A.; Qureshi, M.N.; Aljohani, A.S.M.; Khan, S.A.; Khalil, A.A.; A El-Esawi, M.; Muhammad, N. Synthesis, characterization, biological activities, and catalytic applications of alcoholic extract of saffron (Crocus sativus) flower stigma-based gold nanoparticles. Green Process. Synth. 2021, 10, 230–245. [Google Scholar] [CrossRef]
- Chan, J.Z.; Ali, R.R.; Shameli, K.; Salleh, M.S.N.; Lee, K.X.; Isa, E.M. Green Synthesis of Gold Nanoparticles using Aqueous Extract of ClitoriaTernatea Flower. In IOP Conference Series: Materials Science and Engineering; IOP Publishing: London, UK, 2020; Volume 808. [Google Scholar]
- Valsalam, S.; Agastian, P.; Esmail, G.A.; Ghilan, A.-K.M.; Al-Dhabi, N.A.; Arasu, M.V. Biosynthesis of silver and gold nanoparticles using Musa acuminata colla flower and its pharmaceutical activity against bacteria and anticancer efficacy. J. Photochem. Photobiol. B Biol. 2019, 201, 111670. [Google Scholar] [CrossRef] [PubMed]
- Rajan, A.; Rajan, A.R.; Philip, D. Elettaria cardamomum seed mediated rapid synthesis of gold nanoparticles and its biological activities. OpenNano 2017, 2, 1–8. [Google Scholar] [CrossRef]
- Srinivas, M.; Venkata, R.C.; Kakarla, R.R.; Shetti, N.P.; Reddy, M.S.; Anjanapura, V.R. Novel Co and Ni metal nanostructures as efficient photocatalysts for photodegradation of organic dyes. Mater. Res. Express 2019, 6, 125502. [Google Scholar] [CrossRef]
- Shan, G.; Surampalli, R.Y.; Tyagi, R.D.; Zhang, T.C. Nanomaterials for environmental burden reduction, waste treatment, and nonpoint source pollution control: A review. Front. Environ. Sci. Eng. China 2009, 3, 249–264. [Google Scholar] [CrossRef]
- Savithramma, N.; Rao, M.L.; Rukmini, K.; Devi, P.S. Antimicrobial activity of silver nanoparticles synthesized by using medicinal plants. Int. J. ChemTech Res. 2011, 3, 1394–1402. [Google Scholar]
- Pan, D.; Caruthers, S.D.; Hu, G.; Senpan, A.; Scott, M.J.; Gaffney, P.J.; Wickline, S.A.; Lanza, G.M. Ligand-Directed Nanobialys as Theranostic Agent for Drug Delivery and Manganese-Based Magnetic Resonance Imaging of Vascular Targets. J. Am. Chem. Soc. 2008, 130, 9186–9187. [Google Scholar] [CrossRef] [PubMed] [Green Version]
- Hullmann, A. Measuring and assessing the development of nanotechnology. Scientometrics 2007, 70, 739–758. [Google Scholar] [CrossRef]
- Maheshwari, P.V.; Gupta, N.V. Advances of nanotechnology in healthcare. Int. J. Pharm Tech Res. 2012, 4, 1221–1227. [Google Scholar]
- Savage, N.; Diallo, M.S. Nanomaterials and water purification: Opportunities and challenges. J. Nanoparticle Res. 2005, 7, 331–342. [Google Scholar] [CrossRef]
- Kamat, P.V. Photophysical, photochemical and photocatalytic aspects of metal nanoparticles. J. Phys. Chem. B 2002, 106, 7729–7744. [Google Scholar] [CrossRef]
- Mirkin, C.A.; Letsinger, R.L.; Mucic, R.C.; Storhoff, J.J. A DNA-based method for rationally assembling nanoparticles into macroscopic materials. Nature 1996, 382, 607–609. [Google Scholar] [CrossRef]
- Han, M.; Gao, X.; Su, J.Z.; Nie, S. Quantum-dot-tagged microbeads for multiplexed optical coding of biomolecules. Nature Bio. 2001, 19, 631–635. [Google Scholar] [CrossRef]
- Boncheva, M.; Gracias, D.; Jacobs, H.O.; Whitesides, G.M. Biomimetic self-assembly of a functional asymmetrical electronic device. Proc. Natl. Acad. Sci. 2002, 99, 4937–4940. [Google Scholar] [CrossRef] [Green Version]
- Mishra, A.; Mehta, A.; Basu, S.; Malode, S.J.; Shetti, N.P.; Shukla, S.S.; Nadagouda, M.N.; Aminabhavi, T.M. Electrode materials for lithium-ion batteries. Mater. Sci. Energy Technol. 2018, 1, 182–187. [Google Scholar] [CrossRef]
- Cao, Y.; Jin, R.; Mirkin, C.A. DNA-modified core− shell Ag/Au nanoparticles. J. Am. Chem. Soc. 2001, 123, 7961–7962. [Google Scholar] [CrossRef]
- Barillo, D.J.; Marx, D.E. Silver in medicine: A brief history BC 335 to present. Burns 2014, 40, S3–S8. [Google Scholar] [CrossRef]
- Hong, X.; Wen, J.; Xiong, X.; Hu, Y. Shape effect on the antibacterial activity of silver nanoparticles synthesized via a microwave-assisted method. Environ. Sci. Pollut. Res. 2015, 23, 4489–4497. [Google Scholar] [CrossRef] [PubMed]
- Akbarzadeh, A.; Kafshdooz, L.; Razban, Z.; Tbrizi, A.D.; Rasoulpour, S.; Khalilov, R.; Kavetskyy, T.; Saghfi, S.; Nasibova, A.N.; Kaamyabi, S.; et al. An overview application of silver nanoparticles in inhibition of herpes simplex virus. Artif. Cells, Nanomedicine, Biotechnol. 2017, 46, 263–267. [Google Scholar] [CrossRef]
- Cohan, R.A.; Shoari, A.; Baghbani-Arani, F.; Shandiz, S.A.S.; Khosravy, M.S.; Janani, A.; Bigdeli, R.; Bashar, R.; Asgary, V. Green synthesis and evaluation of silver nanoparticles as adjuvant in rabies veterinary vaccine. Int. J. Nanomed. 2016, 11, 3597–3605. [Google Scholar] [CrossRef] [Green Version]
- Saratale, G.D.; Saratale, R.G.; Benelli, G.; Kumar, G.; Pugazhendhi, A.; Kim, D.-S.; Shin, H.-S. Anti-diabetic Potential of Silver Nanoparticles Synthesized with Argyreia nervosa Leaf Extract High Synergistic Antibacterial Activity with Standard Antibiotics Against Foodborne Bacteria. J. Clust. Sci. 2017, 28, 1709–1727. [Google Scholar] [CrossRef]
- Elsupikhe, R.F.; Shameli, K.; Ahmad, M.B. Sonochemical method for the synthesis of silver nanoparticles in κ-carrageenan from silver salt at different concentrations. Res. Chem. Intermed. 2015, 41, 8515–8525. [Google Scholar] [CrossRef] [Green Version]
- Akter, S.; Lee, S.-Y.; Siddiqi, M.Z.; Balusamy, S.R.; Ashrafudoulla; Rupa, E.J.; Huq, A. Ecofriendly Synthesis of Silver Nanoparticles by Terrabacter humi sp. nov. and Their Antibacterial Application against Antibiotic-Resistant Pathogens. Int. J. Mol. Sci. 2020, 21, 9746. [Google Scholar] [CrossRef] [PubMed]
- Bapat, R.A.; Chaubal, T.V.; Joshi, C.P.; Bapat, P.R.; Choudhury, H.; Pandey, M.; Gorain, B.; Kesharwani, P. An overview of application of silver nanoparticles for biomaterials in dentistry. Mater. Sci. Eng. C 2018, 91, 881–898. [Google Scholar] [CrossRef] [PubMed]
- Chávez-Andrade, G.M.; Tanomaru-Filho, M.; Bernardi, M.I.B.; Leonardo, R.D.T.; Faria, G.; Guerreiro-Tanomaru, J.M. Antimicrobial and biofilm anti-adhesion activities of silver nanoparticles and farnesol against endodontic microorganisms for possible application in root canal treatment. Arch. Oral Biol. 2019, 107, 104481. [Google Scholar] [CrossRef] [PubMed]
- Yamamoto, Y.S.; Ishikawa, M.; Ozaki, Y.; Itoh, T. Fundamental studies on enhancement and blinking mechanism of surface-enhanced Raman scattering (SERS) and basic applications of SERS biological sensing. Front. Phys. 2013, 9, 31–46. [Google Scholar] [CrossRef]
- Abdolmohammad-Zadeh, H.; Azari, Z.; Pourbasheer, E. Fluorescence resonance energy transfer between carbon quantum dots and silver nanoparticles: Application to mercuric ion sensing. Spectrochim. Acta Part A Mol. Biomol. Spectrosc. 2020, 245, 118924. [Google Scholar] [CrossRef]
- Affes, S.; Maalej, H.; Aranaz, I.; Kchaou, H.; Acosta, N.; Heras; Nasri, M. Controlled size green synthesis of bioactive silver nanoparticles assisted by chitosan and its derivatives and their application in biofilm preparation. Carbohydr. Polym. 2020, 236, 116063. [Google Scholar] [CrossRef] [PubMed]
- Rauf, A.; Ahmad, T.; Khan, A.; Maryam; Uddin, G.; Ahmad, B.; Mabkhot, Y.N.; Bawazeer, S.; Riaz, N.; Malikovna, B.K.; et al. Green synthesis and biomedicinal applications of silver and gold nanoparticles functionalized with methanolic extract of Mentha longifolia. Artif. Cells Nanomedicine, Biotechnol. 2021, 49, 194–203. [Google Scholar] [CrossRef]
- Manikandan, D.B.; Sridhar, A.; Sekar, R.K.; Perumalsamy, B.; Veeran, S.; Arumugam, M.; Karuppaiah, P.; Ramasamy, T. Green fabrication, characterization of silver nanoparticles using aqueous leaf extract of Ocimumamericanum (Hoary Basil) and investigation of its in vitro antibacterial, antioxidant, anticancer and photocatalytic reduction. J. Environ. Chem. Eng. 2021, 9, 104845. [Google Scholar] [CrossRef]
- Khan, S.A.; Shahid, S.; Lee, C.S. Green synthesis of gold and silver nanoparticles using leaf extract of clerodendruminerme; characterization, antimicrobial, and antioxidant activities. Biomolecules 2020, 10, 835. [Google Scholar] [CrossRef]
- Okaiyeto, K.; Hoppe, H.; Okoh, A. Plant-Based Synthesis of Silver Nanoparticles Using Aqueous Leaf Extract of Salvia officinalis: Characterization and its Antiplasmodial Activity. J. Clust. Sci. 2020, 32, 101–109. [Google Scholar] [CrossRef] [Green Version]
- Esan, V.; Mahboob, S.; Al-Ghanim, K.A.; Elanchezhiyan, C.; Al-Misned, F.; Ahmed, Z.; Govindarajan, M. Novel biogenic synthesis of silver nanoparticles using Alstonia venenata leaf extract: An enhanced mosquito larvicidal agent with negligible impact on important eco-biological fish and insects. J. Clust. Sci. 2021, 32, 489–497. [Google Scholar] [CrossRef]
- Sooraj, M.P.; Nair, A.S.; Vineetha, D. Sunlight-mediated green synthesis of silver nanoparticles using Sida retusa leaf extract and assessment of its antimicrobial and catalytic activities. Chem. Pap. 2020, 75, 351–363. [Google Scholar] [CrossRef]
- Singh, S.P.; Mishra, A.; Shyanti, R.K.; Singh, R.P.; Acharya, A. Silver nanoparticles synthesized using Carica papaya leaf extract (AgNPs-PLE) causes cell cycle arrest and apoptosis in human prostate (DU145) cancer cells. Biol. Trace Elem. Res. 2021, 199, 1316–1331. [Google Scholar] [CrossRef]
- Singh, R.; Hano, C.; Nath, G.; Sharma, B. Green Biosynthesis of Silver Nanoparticles Using Leaf Extract of Carissa carandas L. and Their Antioxidant and Antimicrobial Activity against Human Pathogenic Bacteria. Biomolecules 2021, 11, 299. [Google Scholar] [CrossRef]
- Al-Otibi, F.; Perveen, K.; Al-Saif, N.A.; Alharbi, R.I.; Bokhari, N.A.; Albasher, G.; Al-Otaibi, R.M.; Al-Mosa, M.A. Biosynthesis of silver nanoparticles using Malva parviflora and their antifungal activity. Saudi J. Biol. Sci. 2021, 28, 2229–2235. [Google Scholar] [CrossRef]
- Padalia, H.; Chanda, S. Synthesis of silver nanoparticles using Ziziphus nummularia leaf extract and evaluation of their antimicrobial, antioxidant, cytotoxic and genotoxic potential (4-in-1 system). Artif. Cells Nanomed. Biotechnol. 2021, 49, 354–366. [Google Scholar] [CrossRef] [PubMed]
- Sharifi-Rad, M.; Pohl, P.; Epifano, F. Phytofabrication of Silver Nanoparticles (AgNPs) with Pharmaceutical Capabilities Using Otostegia persica (Burm.) Boiss. Leaf Extract. Nanomaterials 2021, 11, 1045. [Google Scholar] [CrossRef]
- Abdallah, B.M.; Ali, E.M. Green Synthesis of Silver Nanoparticles Using the Lotus lalambensis Aqueous Leaf Extract and Their Anti-Candidal Activity against Oral Candidiasis. ACS Omega 2021, 6, 8151–8162. [Google Scholar] [CrossRef]
- Panda, M.K.; Dhal, N.K.; Kumar, M.; Mishra, P.M.; Behera, R.K. Green synthesis of silver nanoparticles and its potential effect on phytopathogens. Mater. Today Proc. 2020, 35, 233–238. [Google Scholar] [CrossRef]
- Anju, T.R.; Parvathy, S.; Veettil, M.V.; Rosemary, J.; Ansalna, T.H.; Shahzabanu, M.M.; Devika, S. Green synthesis of silver nanoparticles from Aloe vera leaf extract and its antimicrobial activity. Mater. Today Proc. 2021, 43, 3956–3960. [Google Scholar] [CrossRef]
- Seerangaraj, V.; Sathiyavimal, S.; Shankar, S.N.; Nandagopal, J.G.T.; Balashanmugam, P.; Al-Misned, F.A.; Shanmugavel, M.; Senthilkumar, P.; Pugazhendhi, A. Cytotoxic effects of silver nanoparticles on Ruellia tuberosa: Photocatalytic degradation properties against crystal violet and coomassie brilliant blue. J. Environ. Chem. Eng. 2021, 9, 105088. [Google Scholar] [CrossRef]
- Sharma, Y.; Kawatra, A.; Sharma, V.; Dhull, D.; Kaushik, S.; Yadav, J.P.; Kaushik, S. In-vitro and in-silico evaluation of the anti-chikungunya potential of Psidium guajava leaf extract and their synthesized silver nanoparticles. VirusDisease 2021, 32, 260–265. [Google Scholar] [CrossRef]
- Ekennia, A.C.; Uduagwu, D.N.; Nwaji, N.N.; Olowu, O.J.; Nwanji, O.L.; Ejimofor, M.; Sonde, C.U.; Oje, O.O.; Igwe, D.O. Green synthesis of silver nanoparticles using leaf extract of Euphorbia sanguine: An in vitro study of its photocatalytic and melanogenesis inhibition activity. Inorg. Nano Met. Chem. 2021, 9, 1–9. [Google Scholar] [CrossRef]
- Hazaa, M.; Alm-Eldin, M.; Ibrahim, A.E.; Elbarky, N.; Salama, M.; Sayed, R.; Sayed, W. Biosynthesis of Silver Nanoparticles using Borago officinslis leaf extract, characterization and larvicidal activity against cotton leaf worm, Spodoptera littoralis (Bosid). Int. J. Trop. Insect Sci. 2021, 41, 145–156. [Google Scholar] [CrossRef]
- Seifipour, R.; Nozari, M.; Pishkar, L. Green Synthesis of Silver Nanoparticles using Tragopogon Collinus Leaf Extract and Study of Their Antibacterial Effects. J. Inorg. Organomet. Polym. Mater. 2020, 30, 2926–2936. [Google Scholar] [CrossRef]
- Jebris, S.; Jenana, R.K.B.; Dridi, C. Green synthesis of silver nanoparticles using Melia azedarach leaf extract and their antifungal activities: In vitro and in vivo. Mater. Chem. Phys. 2020, 248, 122898. [Google Scholar] [CrossRef]
- Nouri, A.; Yaraki, M.T.; Lajevardi, A.; Rezaei, Z.; Ghorbanpour, M.; Tanzifi, M. Ultrasonic-assisted green synthesis of silver nanoparticles using Mentha aquatica leaf extract for enhanced antibacterial properties and catalytic activity. Colloid Interface Sci. Commun. 2020, 35, 100252. [Google Scholar] [CrossRef]
- Guimarães, M.L.; da Silva, F.A.G.; da Costa, M.M.; de Oliveira, H.P. Green synthesis of silver nanoparticles using Ziziphus joazeiro leaf extract for production of antibacterial agents. Appl. Nanosci. 2020, 10, 1073–1081. [Google Scholar] [CrossRef]
- Rangayasami, A.; Kannan, K.; Joshi, S.; Subban, M. Bioengineered silver nanoparticles using Elytraria acaulis (L.f.) Lindau leaf extract and its biological applications. Biocatal. Agric. Biotechnol. 2020, 27, 101690. [Google Scholar] [CrossRef]
- Lateef, A.; Oladejo, S.M.; Akinola, P.O.; Aina, D.A.; Beukes, L.S.; Folarin, B.I.; Gueguim-Kana, E.B. Facile synthesis of silver nanoparticles using leaf extract of Hyptissuaveolens (L.) Poit for environmental and biomedical applications. In IOP Conference Series: Materials Science and Engineering; IOP Publishing: London, UK, 2020; Volume 805. [Google Scholar]
- Moteriya, P.; Chanda, S. Green synthesis of silver nanoparticles from Caesalpinia pulcherrima leaf extract and evaluation of their antimicrobial, cytotoxic and genotoxic potential (3-in-1 system). J. Inorg. Organomet. Polym. Mater. 2020, 30, 3920–3932. [Google Scholar] [CrossRef]
- Tamilarasi, P.; Meena, P. Green synthesis of silver nanoparticles (Ag NPs) using Gomphrena globosa (Globe amaranth) leaf extract and their characterization. Mater. Today: Proc. 2020, 33, 2209–2216. [Google Scholar] [CrossRef]
- Govindan, L.; Anbazhagan, S.; Altemimi, A.B.; Lakshminarayanan, K.; Kuppan, S.; Pratap-Singh, A.; Kandasamy, M. Efficacy of Antimicrobial and Larvicidal Activities of Green Synthesized Silver Nanoparticles Using Leaf Extract of Plumbago auriculata Lam. Plants 2020, 9, 1577. [Google Scholar] [CrossRef] [PubMed]
- Hemlata; Meena, P.R.; Singh, A.P.; Tejavath, K.K. Biosynthesis of silver nanoparticles using cucumisprophetarum aqueous leaf extract and their antibacterial and antiproliferative activity against cancer cell lines. ACS Omega 2020, 5, 5520–5528. [Google Scholar] [CrossRef] [PubMed] [Green Version]
- Rawat, V.; Sharma, A.; Bhatt, V.P.; Singh, R.P.; Maurya, I.K. Sunlight mediated green synthesis of silver nanoparticles using Polygonatum graminifolium leaf extract and their antibacterial activity. Mater. Today: Proc. 2020, 29, 911–916. [Google Scholar] [CrossRef]
- Uddin, A.K.M.R.; Siddique, A.B.; Rahman, F.; Ullah, A.K.M.A.; Khan, R. Cocos nucifera Leaf Extract Mediated Green Synthesis of Silver Nanoparticles for Enhanced Antibacterial Activity. J. Inorg. Organomet. Polym. Mater. 2020, 30, 3305–3316. [Google Scholar] [CrossRef]
- Pilaquinga, F.; Amaguaña, D.; Morey, J.; Moncada-Basualto, M.; Pozo-Martínez, J.; Olea-Azar, C.; Fernández, L.; Espinoza-Montero, P.; Jara-Negrete, E.; Meneses, L.; et al. Synthesis of Silver Nanoparticles Using Aqueous Leaf Extract of Mimosa albida (Mimosoideae): Characterization and Antioxidant Activity. Materials 2020, 13, 503. [Google Scholar] [CrossRef] [PubMed] [Green Version]
- Nilavukkarasi, M.; Vijayakumar, S.; Kumar, S.P. Biological synthesis and characterization of silver nanoparticles with Capparis zeylanica L. leaf extract for potent antimicrobial and anti proliferation efficiency. Mater. Sci. Energy Technol. 2020, 3, 371–376. [Google Scholar] [CrossRef]
- Kumar, V.; Singh, S.; Srivastava, B.; Bhadouria, R.; Singh, R. Green synthesis of silver nanoparticles using leaf extract of Holoptelea integrifolia and preliminary investigation of its antioxidant, anti-inflammatory, antidiabetic and antibacterial activities. J. Environ. Chem. Eng. 2019, 7, 103094. [Google Scholar] [CrossRef]
- Parthiban, E.; Manivannan, N.; Ramanibai, R.; Mathivanan, N. Green synthesis of silver-nanoparticles from Annona reticulata leaves aqueous extract and its mosquito larvicidal and anti-microbial activity on human pathogens. Biotechnol. Rep. 2018, 21, e00297. [Google Scholar] [CrossRef]
- Jemilugba, O.T.; Sakho, E.H.M.; Parani, S.; Mavumengwana, V.; Oluwafemi, O.S. Green synthesis of silver nanoparticles using Combretum erythrophyllum leaves and its antibacterial activities. Colloid Interface Sci. Commun. 2019, 31, 100191. [Google Scholar] [CrossRef]
- Behravan, M.; Panahi, A.H.; NaghiZadeh, A.; Ziaee, M.; Mahdavi, R.; Mirzapour, A. Facile green synthesis of silver nanoparticles using Berberis vulgaris leaf and root aqueous extract and its antibacterial activity. Int. J. Biol. Macromol. 2018, 124, 148–154. [Google Scholar] [CrossRef]
- Ahmad, S.; Tauseef, I.; Haleem, K.S.; Khan, K.; Shahzad, M.; Ali, M.; Sultan, F. Synthesis of silver nanoparticles using leaves of Catharanthus roseus and their antimicrobial activity. Appl. Nanosci. 2019, 10, 4459–4464. [Google Scholar] [CrossRef]
- Doan, V.D.; Nguyen, T.D.; Nguyen, T.L.H.; Nguyen, H.T. Green synthesis of silver nanoparticles using aganonerionpolymorphum leaves extract and evaluation of their antibacterial and catalytic activity. Mater. Res. Express 2019, 6, 1150g1. [Google Scholar] [CrossRef]
- Singh, C.; Kumar, J.; Kumar, P.; Chauhan, B.S.; Tiwari, K.N.; Mishra, S.K.; Doan, V.D.; Nguyen, T.D.; Nguyen, T.L.H.; Nguyen, H.T.; et al. Green synthesis of silver nanoparticles using aqueous leaf extract of Premna integrifolia (L.) rich in polyphenols and evaluation of their antioxidant, antibacterial and cytotoxic activity. Biotechnol. Biotechnol. Equip. 2019, 33, 359–371. [Google Scholar] [CrossRef] [Green Version]
- Khan, S.; Singh, S.; Gaikwad, S.; Nawani, N.; Junnarkar, M.; Pawar, S.V. Optimization of process parameters for the synthesis of silver nanoparticles from Piper betle leaf aqueous extract, and evaluation of their antiphytofungal activity. Environ. Sci. Pollut. Res. 2019, 27, 27221–27233. [Google Scholar] [CrossRef] [PubMed]
- Gul, A.; Fozia; Shaheen, A.; Ahmad, I.; Khattak, B.; Ahmad, M.; Ullah, R.; Bari, A.; Ali, S.S.; Alobaid, A.; et al. Green Synthesis, Characterization, Enzyme Inhibition, Antimicrobial Potential, and Cytotoxic Activity of Plant Mediated Silver Nanoparticle Using Ricinus communis Leaf and Root Extracts. Biomolecules 2021, 11, 206. [Google Scholar] [CrossRef] [PubMed]
- Ilahi, I.; Khuda, F.; Sahibzada, M.U.K.; Alghamdi, S.; Ullah, R.; Zakiullah; Dablool, A.S.; Alam, M.; Khan, A.; Khalil, A.A.K. Synthesis of silver nanoparticles using root extract of Duchesnea indica and assessment of its biological activities. Arab. J. Chem. 2021, 14, 103110. [Google Scholar] [CrossRef]
- Arshad, H.; Sami, M.A.; Sadaf, S.; Hassan, U. Salvadora persica mediated synthesis of silver nanoparticles and their antimicrobial efficacy. Sci. Rep. 2021, 11, 1–11. [Google Scholar] [CrossRef] [PubMed]
- Tripathi, D.; Modi, A.; Smita, S.S.; Narayan, G.; Pandey-Rai, S. Biomedical potential of green synthesized silver nanoparticles from root extract of Asparagus officinalis. J. Plant Biochem. Biotechnol. 2021, 1–6. [Google Scholar] [CrossRef]
- Sharifi-Rad, M.; Pohl, P.; Epifano, F.; Álvarez-Suarez, J.M. Green synthesis of silver nanoparticles using Astragalus tribuloides delile. root extract: Characterization, antioxidant, antibacterial, and anti-inflammatory activities. Nanomaterials 2020, 10, 2383. [Google Scholar] [CrossRef]
- Dangi, S.; Gupta, A.; Gupta, D.K.; Singh, S.; Parajuli, N. Green synthesis of silver nanoparticles using aqueous root extract of Berberis asiatica and evaluation of their antibacterial activity. Chem. Data Collect. 2020, 28, 100411. [Google Scholar] [CrossRef]
- Akwu, N.A.; Naidoo, Y.; Singh, M.; Nundkumar, N.; Daniels, A.; Lin, J. Two Temperatures Biogenic Synthesis of Silver Nanoparticles from Grewia lasiocarpa E. Mey. ex Harv. Leaf and Stem Bark Extracts: Characterization and Applications. BioNanoScience 2021, 11, 142–158. [Google Scholar] [CrossRef]
- Devi, N.S.; Padma, Y.; Raju, R.R.V. Green synthesis of silver nanoparticles through reduction with Euphorbia nivulia Buch.-Ham., stem bark extract: Characterization and antimicrobial activity. J. Pharmacogn. Phytother. 2021, 13, 60–67. [Google Scholar]
- Adebayo, I.A.; Usman, A.I.; Shittu, F.B.; Ismail, N.Z.; Arsad, H.; Muftaudeen, T.K.; Samian, M.R. Boswellia dalzielii-mediated silver nanoparticles inhibited acute myeloid leukemia (AML) Kasumi-1 cells by inducing cell cycle arrest. Bioinorg. Chem. Appl. 2020, 2020, 8898360. [Google Scholar] [CrossRef]
- Mahiuddin; Saha, P.; Ochiai, B. Green Synthesis and Catalytic Activity of Silver Nanoparticles Based on Piper chaba Stem Extracts. Nanomaterials 2020, 10, 1777. [Google Scholar] [CrossRef] [PubMed]
- Akintelu, S.A.; Olugbeko, S.C.; Folorunso, F.A.; Oyebamiji, A.K.; Folorunso, A.S. Characterization and Pharmacological Efficacy of Silver Nanoparticles Biosynthesized Using the Bark Extract of Garcinia Kola. J. Chem. 2020, 2020, 1–7. [Google Scholar] [CrossRef]
- Dawodu, F.A.; Onuh, C.U.; Akpomie, K.G.; Unuabonah, E.I. Synthesis of silver nanoparticle from Vigna unguiculata stem as adsorbent for malachite green in a batch system. SN Appl. Sci. 2019, 1, 346. [Google Scholar] [CrossRef] [Green Version]
- Awad, M.A.; Hendi, A.A.; Ortashi, K.M.; Alzahrani, B.; Soliman, D.; Alanazi, A.; Alenazi, W.; Taha, R.M.; Ramadan, R.; El-Tohamy, M.; et al. Biogenic synthesis of silver nanoparticles using Trigonella foenum-graecum seed extract: Characterization, photocatalytic and antibacterial activities. Sens. Actuators A Phys. 2021, 323, 112670. [Google Scholar] [CrossRef]
- Morales-Lozoya, V.; Espinoza-Gómez, H.; Flores-López, L.Z.; Sotelo-Barrera, E.L.; Núñez-Rivera, A.; Cadena-Nava, R.D.; Alonso-Nuñez, G.; Rivero, I.A. Study of the effect of the different parts of Morinda citrifolia L. (noni) on the green synthesis of silver nanoparticles and their antibacterial activity. Appl. Surf. Sci. 2020, 537, 147855. [Google Scholar] [CrossRef]
- Donga, S.; Chanda, S. Facile green synthesis of silver nanoparticles using Mangifera indica seed aqueous extract and its antimicrobial, antioxidant and cytotoxic potential (3-in-1 system). Artif. Cells Nanomed. Biotechnol. 2021, 49, 292–302. [Google Scholar] [CrossRef]
- Jose, V.; Raphel, L.; Aiswariya, K.S.; Mathew, P. Green synthesis of silver nanoparticles using Annona squamosa L. seed extract: Characterization, photocatalytic and biological activity assay. Bioprocess Biosyst. Eng. 2021, 44, 1819–1829. [Google Scholar] [CrossRef] [PubMed]
- Saygi, K.O.; Usta, C. Rosa canina waste seed extract-mediated synthesis of silver nanoparticles and the evaluation of its antimutagenic action in Salmonella typhimurium. Mater. Chem. Phys. 2021, 266, 124537. [Google Scholar] [CrossRef]
- Chand, K.; Jiao, C.; Lakhan, M.N.; Shah, A.H.; Kumar, V.; Fouad, D.E.; Chandio, M.B.; Maitlo, A.A.; Ahmed, M.; Cao, D. Green synthesis, characterization and photocatalytic activity of silver nanoparticles synthesized with Nigella Sativa seed extract. Chem. Phys. Lett. 2020, 763, 138218. [Google Scholar] [CrossRef]
- Mehwish, H.M.; Liu, G.; Rajoka, M.S.R.; Cai, H.; Zhong, J.; Song, X.; Xia, L.; Wang, M.; Aadil, R.M.; Inam-Ur-Raheem, M.; et al. Therapeutic potential of Moringa oleifera seed polysaccharide embedded silver nanoparticles in wound healing. Int. J. Biol. Macromol. 2021, 184, 144–158. [Google Scholar] [CrossRef] [PubMed]
- Khan, I.; Bawazeer, S.; Rauf, A.; Qureshi, M.N.; Muhammad, N.; Al-Awthan, Y.S.; Bahattab, O.; Maalik, A.; Rengasamy, K.R. Synthesis, biological investigation and catalytic application using the alcoholic extract of Black Cumin (BuniumPersicum) seeds-based silver nanoparticles. J. Nanostruct. Chem. 2021, 1–19. [Google Scholar]
- de Carvalho Bernardo, W.L.; Boriollo, M.F.G.; Tonon, C.C.; da Silva, J.J.; Cruz, F.M.; Martins, A.L.; Höfling, J.F.; Spolidorio, D.M.P. Antimicrobial effects of silver nanoparticles and extracts of Syzygiumcumini flowers and seeds: Periodontal, cariogenic and opportunistic pathogens. Arch. Oral Biol. 2021, 125, 105101. [Google Scholar] [CrossRef]
- Kara, Z.; Sabır, A.; Koç, F.; Sabır, F.K.; Avcı, A.; Koplay, M.; Doğan, O. Silver Nanoparticles Synthesis by Grape Seeds (Vitis vinifera L.) Extract and Rooting Effect on Grape Cuttings. Erwerbs-Obstbau 2021, 1–8. [Google Scholar] [CrossRef]
- Alkhathlan, A.H.; AL-Abdulkarim, H.A.; Khan, M.; Khan, M.; AlDobiy, A.; Alkholief, M.; Alshamsan, A.; Alkhathlan, H.Z.; Siddiqui, M.R.H. Ecofriendly Synthesis of Silver Nanoparticles Using Aqueous Extracts of Zingiber officinale (Ginger) and Nigella sativa L. Seeds (Black Cumin) and Comparison of Their Antibacterial Potential. Sustainability 2020, 12, 10523. [Google Scholar] [CrossRef]
- Dinparvar, S.; Bagirova, M.; Allahverdiyev, A.M.; Abamor, E.S.; Safarov, T.; Aydogdu, M.; Aktaş, D. A nanotechnology-based new approach in the treatment of breast cancer: Biosynthesized silver nanoparticles using Cuminum cyminum L. seed extract. J. Photochem. Photobiol. B Biol. 2020, 208, 111902. [Google Scholar] [CrossRef]
- Muthu, K.; Rajeswari, S.; Akilandaeaswari, B.; Nagasundari, S.M.; Rangasamy, R. Synthesis, characterisation and photocatalytic activity of silver nanoparticles stabilised by Punica granatum seeds extract. Mater. Technol. 2020, 36, 684–693. [Google Scholar] [CrossRef]
- Hernández-Morales, L.; Espinoza-Gómez, H.; Flores-López, L.Z.; Sotelo-Barrera, E.L.; Núñez-Rivera, A.; Cadena-Nava, R.D.; Alonso-Núñez, G.; Espinoza, K.A. Study of the green synthesis of silver nanoparticles using a natural extract of dark or white Salvia hispanica L. seeds and their antibacterial application. Appl. Surf. Sci. 2019, 489, 952–961. [Google Scholar] [CrossRef]
- Naidu, K.S.B.; Murugan, N.; Adam, J.K. Biogenic synthesis of silver nanoparticles from avicennia marina seed extract and its antibacterial potential. Bionanoscience 2019, 9, 266–273. [Google Scholar] [CrossRef]
- Rautela, A.; Rani, J.; Das, M.D. Green synthesis of silver nanoparticles from Tectona grandis seeds extract: Characterization and mechanism of antimicrobial action on different microorganisms. J. Anal. Sci. Technol. 2019, 10, 5. [Google Scholar] [CrossRef] [Green Version]
- Palithya, S.; Gaddam, S.A.; Kotakadi, V.S.; Penchalaneni, J.; Golla, N.; Krishna, S.B.N.; Naidu, C.V. Green synthesis of silver nanoparticles using flower extracts of Aervalanata and their biomedical applications. Part. Sci. Technol. 2021, 10, 1–13. [Google Scholar] [CrossRef]
- Hasan, K.F.; Horváth, P.G.; Horváth, A.; Alpár, T. Coloration of woven glass fabric using biosynthesized silver nanoparticles from Fraxinus excelsior tree flower. Inorg. Chem. Commun. 2021, 126, 108477. [Google Scholar] [CrossRef]
- Aravind, M.; Ahmad, A.; Ahmad, I.; Amalanathan, M.; Naseem, K.; Mary, S.M.M.; Parvathiraja, C.; Hussain, S.; Algarni, T.S.; Pervaiz, M.; et al. Critical green routing synthesis of silver NPs using jasmine flower extract for biological activities and photocatalytical degradation of methylene blue. J. Environ. Chem. Eng. 2020, 9, 104877. [Google Scholar] [CrossRef]
- Narkevica, I.; Stradina, L.; Stipniece, L.; Jakobsons, E.; Ozolins, J. Electrophoretic deposition of nanocrystalline TiO 2 particles on porous TiO 2-x ceramic scaffolds for biomedical applications. J. Eur. Ceram. Soc. 2017, 37, 3185–3193. [Google Scholar] [CrossRef]
- Pant, B.; Park, M.; Park, S.-J. TiO2 NPs Assembled into a Carbon Nanofiber Composite Electrode by a One-Step Electrospinning Process for Supercapacitor Applications. Polymers 2019, 11, 899. [Google Scholar] [CrossRef] [PubMed] [Green Version]
- Irshad, M.A.; Nawaz, R.; Rehman, M.Z.U.; Imran, M.; Ahmad, J.; Ahmad, S.; Inam, A.; Razzaq, A.; Rizwan, M.; Ali, S. Synthesis and characterization of titanium dioxide nanoparticles by chemical and green methods and their antifungal activities against wheat rust. Chemosphere 2020, 258, 127352. [Google Scholar] [CrossRef]
- Mollavali, M.; Falamaki, C.; Rohani, S. Efficient light harvesting by NiS/CdS/ZnS NPs incorporated in C, N-co-doped-TiO2 nanotube arrays as visible-light sensitive multilayer photoanode for solar applications. Int. J. Hydrog. Energy 2018, 43, 9259–9278. [Google Scholar] [CrossRef]
- Julkapli, N.M.; Bagheri, S.; Hamid, S.B.A. Recent Advances in Heterogeneous Photocatalytic Decolorization of Synthetic Dyes. Sci. World J. 2014, 2014, 1–25. [Google Scholar] [CrossRef] [Green Version]
- Ziental, D.; Czarczynska-Goslinska, B.; Mlynarczyk, D.T.; Glowacka-Sobotta, A.; Stanisz, B.; Goslinski, T.; Sobotta, L. Titanium Dioxide Nanoparticles: Prospects and Applications in Medicine. Nanomaterials 2020, 10, 387. [Google Scholar] [CrossRef] [PubMed] [Green Version]
- Pirkanniemi, K.; Sillanpää, M. Heterogeneous water phase catalysis as an environmental application: A review. Chemosphere 2002, 48, 1047–1060. [Google Scholar] [CrossRef]
- Valencia, S.; Vargas, X.; Rios, L.; Restrepo, G.; Marín, J.M. Sol–gel and low-temperature solvothermal synthesis of photoactive nano-titanium dioxide. J. Photochem. Photobiol. A Chem. 2012, 251, 175–181. [Google Scholar] [CrossRef]
- Chen, Y.-F.; Tsai, H.-Y.; Wu, T.-S. Anti-Inflammatory and Analgesic Activities from Roots ofAngelica pubescens. Planta Medica 1995, 61, 2–8. [Google Scholar] [CrossRef] [PubMed]
- Jayaseelan, C.; Rahuman, A.A.; Roopan, S.M.; Kirthi, A.V.; Venkatesan, J.; Kim, S.K.; Iyappan, M.; Siva, C. Biological approach to synthesize TiO2 nanoparticles using Aeromonas hydrophila and its antibacterial activity. Spectrochim. Acta Part A Mol. Biomol. Spectrosc. 2013, 107, 82–89. [Google Scholar] [CrossRef] [PubMed]
- Mittal, A.K.; Bhaumik, J.; Kumar, S.; Banerjee, U.C. Biosynthesis of silver nanoparticles: Elucidation of prospective mechanism and therapeutic potential. J. Colloid Interface Sci. 2014, 415, 39–47. [Google Scholar] [CrossRef]
- Khan, M. Preparation, Characterization and Applications of Polyaniline Impregnated Silica Gel for the Identification and Separation of Some Important Organics. Ph.D. Dissertation, Aligarh Muslim University, Aligarh, India, 2018. [Google Scholar]
- Ahmad, W.; Jaiswal, K.K.; Soni, S. Green synthesis of titanium dioxide (TiO2) nanoparticles by using Mentha arvensis leaves extract and its antimicrobial properties. Inorg. Nano Metal Chem. 2020, 50, 1032–1038. [Google Scholar] [CrossRef]
- Narayanan, M.; Devi, P.G.; Natarajan, D.; Kandasamy, S.; Devarayan, K.; Alsehli, M.; Elfasakhany, A.; Pugazhendhi, A. Green synthesis and characterization of titanium dioxide nanoparticles using leaf extract of Pouteria campechiana and larvicidal and pupicidal activity on Aedes aegypti. Environ. Res. 2021, 200, 111333. [Google Scholar] [CrossRef] [PubMed]
- Narayanan, M.; Vigneshwari, P.; Natarajan, D.; Kandasamy, S.; Alsehli, M.; Elfasakhany, A.; Pugazhendhi, A. Synthesis and characterization of TiO2 NPs by aqueous leaf extract of Coleus aromaticus and assess their antibacterial, larvicidal, and anticancer potential. Environ. Res. 2021, 200, 111335. [Google Scholar] [CrossRef] [PubMed]
- Zubair, M.; Husain, F.M.; Qais, F.A.; Alam, P.; Ahmad, I.; Albalawi, T.; Ahmad, N.; Alam, M.; Baig, M.H.; Dong, J.J.; et al. Bio-fabrication of titanium oxide nanoparticles from Ochradenusarabicus to obliterate biofilms of drug-resistant Staphylococcus aureus and Pseudomonas aeruginosa isolated from diabetic foot infections. Appl. Nanosci. 2021, 11, 375–387. [Google Scholar] [CrossRef]
- Ahmad, W.; Singh, A.; Jaiswal, K.K.; Gupta, P. Green Synthesis of Photocatalytic TiO2 Nanoparticles for Potential Application in Photochemical Degradation of Ornidazole. J. Inorg. Organomet. Polym. Mater. 2020, 31, 614–623. [Google Scholar] [CrossRef]
- Thakur, B.; Kumar, A.; Kumar, D. Green synthesis of titanium dioxide nanoparticles using Azadirachta indica leaf extract and evaluation of their antibacterial activity. South Afr. J. Bot. 2019, 124, 223–227. [Google Scholar] [CrossRef]
- Kaur, H.; Kaur, S.; Singh, J.; Rawat, M.; Kumar, S. Expanding horizon: Green synthesis of TiO2 nanoparticles using Carica papaya leaves for photocatalysis application. Mater. Res. Express 2019, 6, 095034. [Google Scholar] [CrossRef]
- Rajkumari, J.; Magdalane, C.M.; Siddhardha, B.; Madhavan, J.; Ramalingam, G.; Al-Dhabi, N.A.; Arasu, M.V.; Ghilan, A.; Duraipandiayan, V.; Kaviyarasu, K. Synthesis of titanium oxide nanoparticles using Aloe barbadensis mill and evaluation of its antibiofilm potential against Pseudomonas aeruginosa PAO1. J. Photochem. Photobiol. B Biol. 2019, 201, 111667. [Google Scholar] [CrossRef]
- Bavanilatha, M.; Yoshitha, L.; Nivedhitha, S.; Sahithya, S. Bioactive studies of TiO2 nanoparticles synthesized using Glycyrrhiza glabra. Biocatal. Agric. Biotechnol. 2019, 19. [Google Scholar] [CrossRef]
- Aravind, M.; Amalanathan, M.; Mary, M.S.M. Synthesis of TiO2 nanoparticles by chemical and green synthesis methods and their multifaceted properties. SN Appl. Sci. 2021, 3, 1–10. [Google Scholar] [CrossRef]
- Sagadevan, S.; Lett, J.A.; Vennila, S.; Prasath, P.V.; Kaliaraj, G.S.; Fatimah, I.; Léonard, E.; Mohammad, F.; Al-Lohedan, H.A.; Alshahateet, S.F.; et al. Photocatalytic activity and antibacterial efficacy of titanium dioxide nanoparticles mediated by Myristica fragrans seed extract. Chem. Phys. Lett. 2021, 771, 138527. [Google Scholar] [CrossRef]
- Mathew, S.S.; Sunny, N.E.; Shanmugam, V. Green synthesis of anatase titanium dioxide nanoparticles using Cuminum cyminum seed extract; effect on Mung bean (Vigna radiata) seed germination. Inorg. Chem. Commun. 2021, 126, 108485. [Google Scholar] [CrossRef]
- Perveen, K.; Husain, F.M.; Qais, F.A.; Khan, A.; Razak, S.; Afsar, T.; Alam, P.; Almajwal, A.M.; Abulmeaty, M. Microwave-Assisted Rapid Green Synthesis of Gold Nanoparticles Using Seed Extract of Trachyspermumammi: ROS Mediated Biofilm Inhibition and Anticancer Activity. Biomolecules 2021, 11, 197. [Google Scholar] [CrossRef] [PubMed]
- Isacfranklin, M.; Yuvakkumar, R.; Ravi, G.; Kumar, P.; Saravanakumar, B.; Velauthapillai, D.; Alahmadi, T.A.; Alharbi, S.A. Biomedical application of single anatase phase TiO2 nanoparticles with addition of Rambutan (Nephelium lappaceum L.) fruit peel extract. Appl. Nanosci. 2020, 11, 699–708. [Google Scholar] [CrossRef]
- Krishnan, B.; Mahalingam, S. Improved surface morphology of silver/copper oxide/bentonite nanocomposite using aliphatic ammonium based ionic liquid for enhanced biological activities. J. Mol. Liq. 2017, 241, 1044–1058. [Google Scholar] [CrossRef]
- Rafea, M.A.; Roushdy, N. Determination of the optical band gap for amorphous and nanocrystalline copper oxide thin films prepared by SILAR technique. J. Phys. D Appl. Phys. 2008, 42, 015413. [Google Scholar] [CrossRef]
- Ren, G.; Hu, D.; Cheng, E.W.; Vargas-Reus, M.A.; Reip, P.; Allaker, R.P. Characterisation of copper oxide nanoparticles for antimicrobial applications. Int. J. Antimicrob. Agents 2009, 33, 587–590. [Google Scholar] [CrossRef]
- Verma, N.; Kumar, N. Synthesis and biomedical applications of copper oxide nanoparticles: An expanding horizon. ACS Biomater. Sci. Eng. 2019, 5, 1170–1188. [Google Scholar] [CrossRef]
- Chang, M.-H.; Liu, H.-S.; Tai, C.Y. Preparation of copper oxide nanoparticles and its application in nanofluid. Powder Technol. 2011, 207, 378–386. [Google Scholar] [CrossRef]
- Devi, H.S.; Singh, T.D. Synthesis of copper oxide nanoparticles by a novel method and its application in the degradation of methyl orange. Adv. Electron. Electr. Eng. 2014, 4, 83–88. [Google Scholar]
- Vasantharaj, S.; Sathiyavimal, S.; Saravanan, M.; Senthilkumar, P.; Gnanasekaran, K.; Shanmugavel, M.; Manikandan, E.; Pugazhendhi, A. Synthesis of ecofriendly copper oxide nanoparticles for fabrication over textile fabrics: Characterization of antibacterial activity and dye degradation potential. J. Photochem. Photobiol. B: Biol. 2018, 191, 143–149. [Google Scholar] [CrossRef]
- Rehana, D.; Mahendiran, D.; Kumar, R.S.; Rahiman, A.K. Evaluation of antioxidant and anticancer activity of copper oxide nanoparticles synthesized using medicinally important plant extracts. Biomed. Pharmacother. 2017, 89, 1067–1077. [Google Scholar] [CrossRef] [PubMed]
- Obaid, M.A.; Harbi, K.H.; Abd, A.N. Study the effect of antibacterial on the chemically prepared copper oxide. Mater. Today: Proc. 2021, 47, 6006–6010. [Google Scholar]
- Singh, A.; Singh, N.; Hussain, I.; Singh, H. Effect of biologically synthesized copper oxide nanoparticles on metabolism and antioxidant activity to the crop plants Solanum lycopersicum and Brassica oleracea var. botrytis. J. Biotechnol. 2017, 262, 11–27. [Google Scholar] [CrossRef] [PubMed]
- Singh, S.; Kumar, N.; Kumar, M.; Jyoti; Agarwal, A.; Mizaikoff, B. Electrochemical sensing and remediation of 4-nitrophenol using bio-synthesized copper oxide nanoparticles. Chem. Eng. J. 2017, 313, 283–292. [Google Scholar] [CrossRef]
- Nasrollahzadeh, M.; Sajadi, S.M.; Rostami-Vartooni, A.; Hussin, S.M. Green synthesis of CuO nanoparticles using aqueous extract of Thymus vulgaris L. leaves and their catalytic performance for N-arylation of indoles and amines. J. Colloid Interface Sci. 2016, 466, 113–119. [Google Scholar] [CrossRef] [PubMed]
- Yatish, K.; Prakash, R.M.; Ningaraju, C.; Sakar, M.; GeethaBalakrishna, R.; Lalithamba, H. Terminalia chebula as a novel green source for the synthesis of copper oxide nanoparticles and as feedstock for biodiesel production and its application on diesel engine. Energy 2020, 215, 119165. [Google Scholar] [CrossRef]
- Ramzan, M.; Obodo, R.; Mukhtar, S.; Ilyas, S.; Aziz, F.; Thovhogi, N. Green synthesis of copper oxide nanoparticles using Cedrus deodara aqueous extract for antibacterial activity. Mater. Today: Proc. 2020, 36, 576–581. [Google Scholar] [CrossRef]
- Sathiyavimal, S.; Vasantharaj, S.; Veeramani, V.; Saravanan, M.; Rajalakshmi, G.; Kaliannan, T.; Al-Misned, F.A.; Pugazhendhi, A. Green chemistry route of biosynthesized copper oxide nanoparticles using Psidium guajava leaf extract and their antibacterial activity and effective removal of industrial dyes. J. Environ. Chem. Eng. 2021, 9, 105033. [Google Scholar] [CrossRef]
- Elakkiya, V.T.; Meenakshi, R.V.; Kumar, P.S.; Karthik, V.; Shankar, K.R.; Sureshkumar, P.; Hanan, A. Green synthesis of copper nanoparticles using Sesbania aculeata to enhance the plant growth and antimicrobial activities. Int. J. Environ. Sci. Technol. 2021, 1–10. [Google Scholar] [CrossRef]
- Mali, S.C.; Dhaka, A.; Githala, C.K.; Trivedi, R. Green synthesis of copper nanoparticles using CelastruspaniculatusWilld. leaf extract and their photocatalytic and antifungal properties. Biotechnol. Rep. 2020, 27, e00518. [Google Scholar] [CrossRef]
- Andualem, W.W.; Sabir, F.K.; Mohammed, E.T.; Belay, H.H.; Gonfa, B.A. Synthesis of Copper Oxide Nanoparticles Using Plant Leaf Extract of Catha edulis and Its Antibacterial Activity. J. Nanotechnol. 2020, 2020, 1–10. [Google Scholar] [CrossRef]
- Chandraker, S.K.; Lal, M.; Ghosh, M.K.; Tiwari, V.; Ghorai, T.K.; Shukla, R. Green synthesis of copper nanoparticles using leaf extract of Ageratum houstonianum Mill. and study of their photocatalytic and antibacterial activities. Nano Express 2020, 1, 010033. [Google Scholar] [CrossRef]
- Ghosh, M.K.; Sahu, S.; Gupta, I.; Ghorai, T.K. Green synthesis of copper nanoparticles from an extract of Jatropha curcas leaves: Characterization, optical properties, CT-DNA binding and photocatalytic activity. RSC Adv. 2020, 10, 22027–22035. [Google Scholar] [CrossRef]
- Rafique, M.; Shafiq, F.; Gillani, S.S.A.; Shakil, M.; Tahir, M.B.; Sadaf, I. Eco-friendly green and biosynthesis of copper oxide nanoparticles using Citrofortunella microcarpa leaves extract for efficient photocatalytic degradation of Rhodamin B dye form textile wastewater. Optik 2020, 208, 164053. [Google Scholar] [CrossRef]
- Mali, S.C.; Raj, S.; Trivedi, R. Biosynthesis of copper oxide nanoparticles using Enicostemmaaxillare (Lam.) leaf extract. Biochem. Biophys. Rep. 2019, 20, 100699. [Google Scholar]
- Ahmed, A.; Usman, M.; Liu, Q.-Y.; Shen, Y.-Q.; Yu, B.; Cong, H.-L. Plant mediated synthesis of copper nanoparticles by using Camelia sinensis leaves extract and their applications in dye degradation. Ferroelectrics 2019, 549, 61–69. [Google Scholar] [CrossRef]
- Singh, P.; Singh, K.R.; Singh, J.; Das, S.N.; Singh, R.P. Tunable electrochemistry and efficient antibacterial activity of plant-mediated copper oxide nanoparticles synthesized by Annona squamosa seed extract for agricultural utility. RSC Adv. 2021, 11, 18050–18060. [Google Scholar] [CrossRef]
- Jahagirdar, A.S.; Shende, S.; Gade, A.; Rai, M. Bioinspired Synthesis of Copper Nanoparticles and its Efficacy on Seed Viability and Seedling Growth in Mungbean (Vigna radiata L.). Curr. Nanosci. 2020, 16, 246–252. [Google Scholar] [CrossRef]
- Venkatramanan, A.; Ilangovan, A.; Thangarajan, P.; Saravanan, A.; Mani, B. Green Synthesis of Copper Oxide Nanoparticles (CuO NPs) From Aqueous Extract of Seeds of Eletteria Cardamomum and Its Antimicrobial Activity against Pathogens. Curr. Biotechnol. 2021, 9, 304–311. [Google Scholar] [CrossRef]
- Buazar, F.; Sweidi, S.; Badri, M.; Kroushawi, F. Biofabrication of highly pure copper oxide nanoparticles using wheat seed extract and their catalytic activity: A mechanistic approach. Green Process. Synth. 2019, 8, 691–702. [Google Scholar] [CrossRef]
- Roy, K.; Ghosh, C.K.; Sarkar, C.K. Selective amino acid detection by green synthesized copper nanoparticles prepared using basil (Ocimumtenuiflorum) flower extract. Microsyst. Technol. 2021, 27, 353–357. [Google Scholar] [CrossRef]
- Veisi, H.; Karmakar, B.; Tamoradi, T.; Hemmati, S.; Hekmati, M.; Hamelian, M. Biosynthesis of CuO nanoparticles using aqueous extract of herbal tea (Stachys Lavandulifolia) flowers and evaluation of its catalytic activity. Sci. Rep. 2021, 11, 1–13. [Google Scholar] [CrossRef]
- Siddiqui, V.U.; Ansari, A.; Chauhan, R.; Siddiqi, W.A. Green synthesis of copper oxide (CuO) nanoparticles by Punica granatum peel extract. Mater. Today: Proc. 2020, 36, 751–755. [Google Scholar] [CrossRef]
- Ramimoghadam, D.; Bagheri, S.; Hamid, S.B.A. Progress in electrochemical synthesis of magnetic iron oxide nanoparticles. J. Magn. Magn. Mater. 2014, 368, 207–229. [Google Scholar] [CrossRef]
- Teja, A.S.; Koh, P.Y. Synthesis, properties, and applications of magnetic iron oxide nanoparticles. Prog. Cryst. Growth Charact. Mater. 2009, 2, 22–45. [Google Scholar] [CrossRef]
- Faraji, M.; Yamini, Y.; Rezaee, M. Magnetic nanoparticles: Synthesis, stabilization, functionalization, characterization, and applications. J. Iran. Chem. Soc. 2010, 7, 1–37. [Google Scholar] [CrossRef]
- Arjaghi, S.K.; Alasl, M.K.; Sajjadi, N.; Fataei, E.; Rajaei, G.E. Green Synthesis of Iron Oxide Nanoparticles by RS Lichen Extract and its Application in Removing Heavy Metals of Lead and Cadmium. Biol. Trace Elem. Res. 2021, 199, 763–768. [Google Scholar] [CrossRef] [PubMed]
- Ardakani, L.S.; Alimardani, V.; Tamaddon, A.M.; Amani, A.M.; Taghizadeh, S. Green synthesis of iron-based nanoparticles using Chlorophytum comosum leaf extract: Methyl orange dye degradation and antimicrobial properties. Heliyon 2021, 7, e06159. [Google Scholar] [CrossRef] [PubMed]
- Jamzad, M.; Bidkorpeh, M.K. Green synthesis of iron oxide nanoparticles by the aqueous extract of Laurus nobilis L. leaves and evaluation of the antimicrobial activity. J. Nanostructure Chem. 2020, 10, 193–201. [Google Scholar] [CrossRef]
- Bhuiyan, S.H.; Miah, M.Y.; Paul, S.C.; Das Aka, T.; Saha, O.; Rahaman, M.; Sharif, J.I.; Habiba, O. Ashaduzzaman Green synthesis of iron oxide nanoparticle using Carica papaya leaf extract: Application for photocatalytic degradation of remazol yellow RR dye and antibacterial activity. Heliyon 2020, 6, e04603. [Google Scholar] [CrossRef] [PubMed]
- Vitta, Y.; Figueroa, M.; Calderon, M.; Ciangherotti, C. Synthesis of iron nanoparticles from aqueous extract of Eucalyptus robustaSm and evaluation of antioxidant and antimicrobial activity. Mater. Sci. Energy Technol. 2020, 3, 97–103. [Google Scholar]
- Vasantharaj, S.; Sathiyavimal, S.; Senthilkumar, P.; LewisOscar, F.; Pugazhendhi, A. Biosynthesis of iron oxide nanoparticles using leaf extract of Ruellia tuberosa: Antimicrobial properties and their applications in photocatalytic degradation. J. Photochem. Photobiol. B Biol. 2019, 192, 74–82. [Google Scholar] [CrossRef]
- Lohrasbi, S.; Kouhbanani, M.A.J.; Beheshtkhoo, N.; Ghasemi, Y.; Amani, A.M.; Taghizadeh, S. Green Synthesis of Iron Nanoparticles Using Plantago major Leaf Extract and Their Application as a Catalyst for the Decolorization of Azo Dye. BioNanoScience 2019, 9, 317–322. [Google Scholar] [CrossRef]
- Karpagavinayagam, P.; Vedhi, C. Green synthesis of iron oxide nanoparticles using Avicennia marina flower extract. Vacuum 2018, 160, 286–292. [Google Scholar] [CrossRef]
- Bibi, I.; Nazar, N.; Ata, S.; Sultan, M.; Ali, A.; Abbas, A.; Jilani, K.; Kamal, S.; Sarim, F.M.; Khan, M.I.; et al. Green synthesis of iron oxide nanoparticles using pomegranate seeds extract and photocatalytic activity evaluation for the degradation of textile dye. J. Mater. Res. Technol. 2019, 8, 6115–6124. [Google Scholar] [CrossRef]
- Sandhya, J.; Kalaiselvam, S. Biogenic synthesis of magnetic iron oxide nanoparticles using inedible borassus flabellifer seed coat: Characterization, antimicrobial, antioxidant activity and in vitro cytotoxicity analysis. Mater. Res. Express 2019, 7, 015045. [Google Scholar] [CrossRef]
- Aziz, W.J.; Abid, M.A.; Kadhim, D.A.; Mejbel, M.K. Synthesis of iron oxide (β-fe2o3) nanoparticles from Iraqi grapes extract and its biomedical application. In IOP Conference Series: Materials Science and Engineering; IOP Publishing: London, UK, 2020; Volume 881. [Google Scholar]
- Rostamizadeh, E.; Iranbakhsh, A.; Majd, A.; Arbabian, S.; Mehregan, I. Green synthesis of Fe2O3 nanoparticles using fruit extract of Cornus mas L. and its growth-promoting roles in Barley. J. Nanostructure Chem. 2020, 10, 125–131. [Google Scholar] [CrossRef]
- Iravani, S.; Varma, R.S. Sustainable synthesis of cobalt and cobalt oxide nanoparticles and their catalytic and biomedical applications. Green Chem. 2020, 22, 2643–2661. [Google Scholar] [CrossRef]
- Yu, Y.; Mendoza-Garcia, A.; Ning, B.; Sun, S. Cobalt-substituted magnetite nanoparticles and their assembly into ferrimagnetic nanoparticle arrays. Adv. Mater. 2013, 25, 3090–3094. [Google Scholar] [CrossRef] [PubMed]
- Raveau, B.; Seikh, M.M. Charge ordering in cobalt oxides: Impact on structure, magnetic and transport properties. Z. Anorg. Allg. Chem. 2015, 9, 1385–1394. [Google Scholar] [CrossRef]
- Liu, J.; Wang, Z.; Yan, X.; Jian, P. Metallic cobalt nanoparticles imbedded into ordered mesoporous carbon: A non-precious metal catalyst with excellent hydrogenation performance. J. Colloid Interface Sci. 2017, 505, 789–795. [Google Scholar] [CrossRef] [PubMed]
- Su, Y.; Zhu, Y.; Jiang, H.; Shen, J.; Yang, X.; Zou, W.; Chen, J.; Li, C. Cobalt nanoparticles embedded in N-doped carbon as an efficient bifunctional electrocatalyst for oxygen reduction and evolution reactions. Nanoscale 2014, 6, 15080–15089. [Google Scholar] [CrossRef]
- Diallo, A.; Beye, A.; Doyle, T.; Park, E.; Maaza, M. Green synthesis of Co3O4nanoparticles viaAspalathus linearis: Physical properties. Green Chem. Lett. Rev. 2015, 8, 30–36. [Google Scholar] [CrossRef] [Green Version]
- Memon, S.A.; Hassan, D.; Buledi, J.A.; Solangi, A.R.; Memon, S.Q.; Palabiyik, I.M. Plant material protected cobalt oxide nanoparticles: Sensitive electro-catalyst for tramadol detection. Microchem. J. 2020, 159, 105480. [Google Scholar] [CrossRef]
- Khan, M.A.; Ali, F.; Faisal, S.; Rizwan, M.; Hussain, Z.; Zaman, N.; Afsheen, Z.; Uddin, M.N.; Bibi, N. Exploring the therapeutic potential of Hibiscus rosa sinensis synthesized cobalt oxide (Co3O4-NPs) and magnesium oxide nanoparticles (MgO-NPs). Saudi J. Biol. Sci. 2021, 28, 5157–5167. [Google Scholar]
- Khadhim, A.I.; Kadhim, R.E. Synthesis of Cobalt Nanoparticles Biologically by Conocarpus erectus L. Aqueous Leaves Extract. Ann. Rom. Soc. Cell Biol. 2021, 25, 5361–5372. [Google Scholar]
- Raeisi, M.; Alijani, H.Q.; Peydayesh, M.; Khatami, M.; Baravati, F.B.; Borhani, F.; Šlouf, M.; Soltaninezhad, S. Magnetic cobalt oxide nanosheets: Green synthesis and in vitro cytotoxicity. Bioprocess Biosyst. Eng. 2021, 44, 1423–1432. [Google Scholar] [CrossRef]
- Akhlaghi, N.; Najafpour-Darzi, G.; Younesi, H. Facile and green synthesis of cobalt oxide nanoparticles using ethanolic extract of Trigonella foenumgraceum (Fenugreek) leaves. Adv. Powder Technol. 2020, 31, 3562–3569. [Google Scholar] [CrossRef]
- Hafeez, M.; Shaheen, R.; Akram, B.; Abdin, Z.U.; Haq, S.; Mahsud, S.; Ali, S.; Khan, R.T. Green synthesis of cobalt oxide nanoparticles for potential biological applications. Mater. Res. Express 2020, 7, 025019. [Google Scholar] [CrossRef]
- Iqbal, J.; Abbasi, B.A.; Batool, R.; Khalil, A.T.; Hameed, S.; Kanwal, S.; Ullah, I.; Mahmood, T. Biogenic synthesis of green and cost effective cobalt oxide nanoparticles using Geranium wallichianum leaves extract and evaluation of in vitro antioxidant, antimicrobial, cytotoxic and enzyme inhibition properties. Mater. Res. Express 2019, 6, 115407. [Google Scholar] [CrossRef]
- Sondi, I.; Salopek-Sondi, B. Silver nanoparticles as antimicrobial agent: A case study on E. coli as a model for Gram-negative bacteria. J. Colloid Interface Sci. 2004, 275, 177–182. [Google Scholar] [CrossRef]
- Kasthuri, J.; Kathiravan, K.; Rajendiran, N. Phyllanthin-assisted biosynthesis of silver and gold nanoparticles: A novel biological approach. J. Nanoparticle Res. 2008, 11, 1075–1085. [Google Scholar] [CrossRef]
- Ansari, M.A.; Khan, H.M.; Khan, A.A. Evaluation of antibacterial activity of silver nanoparticles against MSSA and MSRA on isolates from skin infections. Biol. Med. 2011, 3, 141–146. [Google Scholar]
- Kaviya, S.; Santhanalakshmi, J.; Viswanathan, B.; Muthumary, J.; Srinivasan, K. Biosynthesis of silver nanoparticles using citrus sinensis peel extract and its antibacterial activity. Spectrochim. Acta Part A: Mol. Biomol. Spectrosc. 2011, 79, 594–598. [Google Scholar] [CrossRef]
- Logeswari, P.; Silambarasan, S.; Abraham, J. Synthesis of silver nanoparticles using plants extract and analysis of their antimicrobial property. J. Saudi Chem. Soc. 2015, 19, 311–317. [Google Scholar] [CrossRef] [Green Version]
- Gardea-Torresdey, J.L.; Parsons, J.G.; Gomez, E.; Peralta-Videa, J.; Troiani, H.E.; Santiago, P.; Yacaman, M.J. Formation and Growth of Au Nanoparticles inside Live Alfalfa Plants. Nano Lett. 2002, 2, 397–401. [Google Scholar] [CrossRef]
- Akhtar, M.S.; Panwar, J.; Yun, Y.-S. Biogenic Synthesis of Metallic Nanoparticles by Plant Extracts. ACS Sustain. Chem. Eng. 2013, 1, 591–602. [Google Scholar] [CrossRef]
- Raghunandan, D.; Ravishankar, B.; Sharanbasava, G.; Mahesh, D.B.; Harsoor, V.; Yalagatti, M.S.; Bhagawanraju, M.; Venkataraman, A. Anti-cancer studies of noble metal nanoparticles synthesized using different plant extracts. Cancer Nanotechnol. 2011, 2, 57–65. [Google Scholar] [CrossRef] [PubMed] [Green Version]
- Das, S.; Das, J.; Samadder, A.; Bhattacharyya, S.S.; Das, D.; Khuda-Bukhsh, A.R. Biosynthesized silver nanoparticles by ethanolic extracts of Phytolacca decandra, Gelsemium sempervirens, Hydrastis canadensis and Thuja occidentalis induce differential cytotoxicity through G2/M arrest in A375 cells. Colloids Surfaces B: Biointerfaces 2013, 101, 325–336. [Google Scholar] [CrossRef]
- Alt, V.; Bechert, T.; Steinrücke, P.; Wagener, M.; Seidel, P.; Dingeldein, E.; Domann, E.; Schnettler, R. An in vitro assessment of the antibacterial properties and cytotoxicity of nanoparticulate silver bone cement. Biomaterials 2004, 25, 4383–4391. [Google Scholar] [CrossRef]

| Sr. No | Reducing Agent | Part of Plant | Size | Shape | Biological Activities | Year of Publication | Ref. |
|---|---|---|---|---|---|---|---|
| 1 | Walnut leaf | Leaf | 15–40 nm | Triangular | E. coli (ZOI = 7–9 mm) and S. aureus | 2021 | [79] |
| 2 | Lippia adoensis | Leaf | 22.6–26.8 nm | Predominantly spherical | S. aureus (ZOI = 6–14 mm), E. faecalis (ZOI = 6–10 mm), E. coli (ZOI = 6–12 mm) and K. pneumonia (ZOI = 6–12 mm) | 2021 | [80] |
| 3 | Cayratia pedata | Leaf | 52.24 nm. | - | Utilized in the immobilization of the enzyme (Glucose oxidase) | 2021 | [81] |
| 4 | Piper betle | Leaf | 112 nm | Hexagonal shape and spherical | S. aureus (ZOI = 2–3 mm) and E. coli (ZOI = 1–4 mm) | 2021 | [82] |
| 5 | Becium grandiflorum | Leaf | 20 nm | - | S. aureus (ZOI = 7 mm) E. coli, (ZOI = 6 mm), K. pneumonia (ZOI = 8 mm), and P. aeruginosa (ZOI = 11 mm) Degradation of methylene blue (69% degraded after 200 min) | 2021 | [83] |
| 6 | Achyranthes aspera | Leaf | 28.63–61.42 nm | Hexagonal | S. gallinarum (MIC ≥ 0.195 mg ± 0.00) and S. enteritidis (MIC ≥ 0.390mg ± 0.00) | 2021 | [84] |
| 7 | Arthrospira platensis | Leaf | 30–55 nm | Spherical | subtilis (ZOI = 24.1 ± 0.3 mm), S. aureus (ZOI = 21.1 ± 0.06 mm), P. aeruginosa (ZOI = 19.1 ± 0.3 mm), E. coli (ZOI = 19.9 ± 0.1 mm), and C. albicans (ZOI = 21.6 ± 0.6 mm) Showed significantly high cytotoxic efficacy against cancerous cell | 2021 | [85] |
| 8 | Sambucus ebulus | Leaf | 17 nm | Hexagonal | cereus, S. aureus, and E. coli Photo-catalytic degradation of Methylene blue ((80% degraded after 200 min) | 2020 | [86] |
| 9 | Anacardium occidentale | Leaf | 107.03 ± 1.54 nm and 206.58 ± 1.86 nm | Spherical | S. aureus (ZOI = 1.06 ± 0.14 mm), E. aquaticum (ZOI = 1.99 ± 0.11 mm), K. pneumoniae (ZOI = 2.08 ± 0.03 mm), E. coli (ZOI = 1.49 ± 0.09 mm), and A. baumanii (ZOI = 2.99 ± 0.01 mm) | 2021 | [87] |
| 10 | Eucalyptus globulus Labill. | Leaf | 27–35 nm | - | - | 2020 | [88] |
| 11 | Cassia fistula and Melia azadarach | Leaf | 3–68 nm | - | Cassia fistula E. coli (ZOI = 21 ± 0.68 mm at 10 µL) and (ZOI = 44 ± 3.00 mm at 200 µL) and S. aureus (ZOI = 14 ± 0.54 mm at 10 µL) and (ZOI = 32 ± 2.30 mm at 200 µL) Melia azadarach E. coli (ZOI = 20 ± 0.56 mm at 10 µL) and (ZOI = 40 ± 0.48 mm at 200 µL) and S. aureus (ZOI = 21 ± 0.68 mm at 10 µL and (ZOI = 38 ± 0.55 mm at 200 µL) | 2020 | [89] |
| 12 | Euphorbia hirta | Leaf | 5–20 nm in diameter | - | - | 2020 | [90] |
| 13 | saffron leaf | Leaf | Less than 50 nm in diameter | Spherical | At 25 (μg/disc) Concen of ZnOPs S. Typhimurium (ZOI = 12 ± 0.27 mm), L. monocytogenes (ZOI = -), and E. faecalis (ZOI = 11 ± 0.39 mm). At 50 (μg/disc) Concen of ZnOPs S. Typhimurium (ZOI = 23 ± 0.29 mm), L. monocytogenes (ZOI = -), and E. faecalis (ZOI = 14 ± 0.30 mm). At 50 (μg/disc) Concen of ZnOPs S. Typhimurium (ZOI = 26 ± 0.27 mm), L. monocytogenes (ZOI = -), and E. faecalis (ZOI = 18 ± 0.39 mm). Free radical scavenging activity was reported in DPPH and FRAP (64%). Degradation of methylene blue (69% degraded after 200 min). | 2020 | [91] |
| 14 | Azadirachta Indica | Leaf | 25.97 nm | Hexagonal | E. coli (ZOI = 9.3 mm), Degradation of methylene blue (Degraded 35.5%. 45.7%, 63.9%, 72.1%, and 80.2% at 40, 80, 120, 160, and 200 min, respectively). | 2020 | [92] |
| 15 | Aquilegia pubiflora | Leaf | 34.23 nm | Spherical or elliptical | aeruginosa (ZOI = 10.3 ± 0.19 mm) and F. solani (ZOI = 13 ± 14 mm) Antiparasitic potential. | 2020 | [93] |
| 16 | Broccoli extract | Leaf | 4–17 nm | Hexagonal | Catalytic activity against methylene blue (74%) and phenol red (71%). | 2019 | [94] |
| 17 | Costus igneus | Leaf | 26.55 nm | Hexagonal | At 40 (μg/mL) Concen of ZnOPs S. mutans (ZOI = 2.83 ± 0.15 mm), L. fusiformis (ZOI = 4.73 ± 0.25 mm), P. vulgaris (ZOI = 4.13 ± 0.14 mm), and V. parahaemolyticus (ZOI = 4.2 ± 0.1 mm). At 50 (μg/mL) Concen of ZnOPs S. mutans (ZOI = 4.83 ± 0.15 mm), L. fusiformis (ZOI = 6.6 ± 0.1 mm), P. vulgaris (ZOI = 5.3 ± 0.2 mm), and V. parahaemolyticus (ZOI = 5.13 ± 0.17 mm). At 70 (μg/mL) Concen of ZnOPs S. mutans (ZOI = 5.86 ± 0.18 mm), L. fusiformis (ZOI = 8.53 ± 0.20 mm), P. vulgaris (ZOI = 6.33 ± 0.15 mm), and V. parahaemolyticus (ZOI = 6.56 ± 0.11 mm). Antidiabetic activity. Free radical scavenging activity was reported in DPPH (75%) | 2019 | [95] |
| 18 | Pandanus odorifer | Leaf | 90 nm | Spherical | B. subtilis (ZOI = 26 mm) and Gram-negative E. coli (ZOI = 24 mm). | 2019 | [96] |
| 19 | Solanum torvum | Leaf | 34–40 nm | Spherical | Decreased serum uric acid level. Could affect hepatic and renal performance in rats. | 2019 | [97] |
| Sr. No | Reducing Agent | Part of Plant | Size | Shape | Biological Activities | Year of Publication | Ref. |
|---|---|---|---|---|---|---|---|
| 1 | Rubus Fairholmianus | Root | 11.44 nm | Spherical | S. aureus (MIC = 157.22 μg/mL) | 2021 | [98] |
| 2 | Phoenix dactylifera | Root hair | 30.87–47.89 nm | - | K. pneumoniae (ZOI = 2.4 cm), S. aureus (ZOI = 3.0 cm), Salmonella typhi (ZOI = 2.8 cm), E. coli (ZOI = 2.7 cm), and P. aeruginosa (ZOI = 1.6 cm) Anticancer cytotoxicity | 2021 | [99] |
| 3 | Raphanus sativus | Root | 15 and 25 nm | Hexagonal | S. aureus (ZOI = 21.23 ± 1.16 mm) and E. faecalis (ZOI = 11.23 ± 0.58 mm) | 2020 | [100] |
| 4 | Sphagneticola trilobata L | Root | - | Irregular | - | 2020 | [101] |
| 5 | Moringa oleifera | Root | ~25 nm | Hexagonal | B. Subtilis (ZOI = 12.5 mm) and E. coli (ZOI = 11.6 cm) | 2020 | [102] |
| Sr. No | Reducing Agent | Part of Plant | Size | Shape | Biological Activities | Year of Publication | Ref. |
|---|---|---|---|---|---|---|---|
| 1 | Amygdalus scoparia | Stem | - | - | At 100 (μg/mL) Concen of ZnOPs B. Subtilis (ZOI = 25 mm), S. aureus (ZOI = 28 mm), S. typhimurium (ZOI = 21 mm), E. coli (ZOI = 28 mm), E. aerogenes (ZOI = 22 mm), K. aerogenes (ZOI = 21 mm), P. oryzae (ZOI = 18 mm), C. glabrata (ZOI = 16 mm), F. thapsinum (ZOI = 16 mm), C. albicans (ZOI = 16 mm), F. semitectum (ZOI = 18 mm), and C. neoformans (ZOI = 18 mm) Exhibited excellent photocatalytic activity Exhibited excellent inhibitory effect on cancer line | 2021 | [103] |
| 2 | Cinnamomum verum | Stem bark | - | Hexagonal | aureus (MIC = 125 μg/mL) and E. coli (MIC = 62.5 μg/mL) | 2020 | [104] |
| 3 | Mussaenda frondose | Stem bark | 5–20 nm | Hexagonal | S. aureus (ZOI = 21.51 mm), B. subtilis (ZOI = 19.13 mm), and P. aeruginosa (ZOI = 20.31 mm). Photocatalytic activity and biological applications such as antidiabetic, anticancerous, anti-inflammatory, and antimicrobial activity | 2020 | [105] |
| 4 | Albizia lebbeck | Stem bark | - | - | Tested against S. aureus (ZOI = 4.50 ± 0.30 mm), B. cereus (ZOI = 8.83 ± 0.42 mm), S. typhi (ZOI = 91.3 ± 0.41mm), K. pneumonia (ZOI = 7.30 ± 0.29 mm), and E. coli (ZOI = 10.57 ± 0.320). Free radical scavenging activity was reported in H2O2 (IC50 0f 48.5, 48.7, and 60.2 μg/mL for 0.1 M, 0.05 M, and 0.05 M, respectively) and cytotoxicity against breast MD-MB and MCF-7 cancer cell lines | 2019 | [106] |
| Sr. No | Reducing Agent | Part of Plant | Size | Shape | Biological Activities | Year of Publication | Ref. |
|---|---|---|---|---|---|---|---|
| 1 | Cassia auriculata | Flower | - | Flake structured | S. pneumonia, S. aureus, E. coli, and K. pneumonia (the size of zone observed ranged from 18 mm to 25 mm against the abovementioned pathogens) Anticancer agent against MG-63 cells (15 and 20 μg) | 2021 | [107] |
| 2 | Punica granatum | Flower | - | Irregular shaped | At 100 (μg/mL) Concen of ZnOPs S. diarizonae (ZOI = 10.00 mm), B. cereus (ZOI = 12.33 ± 0.58 mm), S. aureus (ZOI = 10.50 ± 0.87 mm), P. aeruginosa (ZOI = 10.00 ± 1.00 mm), S. pneumonia (ZOI = 14.00 ± 1.00 mm), K. pneumonia (ZOI = 11.00 ± 1.00 mm), E. faecalis (ZOI = 9.67 ± 0.58 mm), S. typhi (ZOI = 8.67 ± 1.15 mm), E. coli (ZOI = 10.00 ± 1.00 mm), L. monocytogenes (ZOI = 14.33 ± 0.58 mm), E. faecium (ZOI = 15.83 ± 0.76 mm), A. hydrophila (ZOI = 13.83 ± 0.29 mm), and M. catarrhalis (ZOI = 12.00 ± 1.00 mm) | 2020 | [108] |
| 3 | Moringa Oleifera | - | 13.2 nm | - | - | 2020 | [109] |
| 4 | Matricaria chamomillaL | Flower | 62.4 nm | - | Pv. Oryzae (ZOI = 2.2 cm) | 2019 | [110] |
| 5 | Syzygium aromaticum | Flower | 30–40 nm | Triangular and hexagonal | Potential application in agriculture and food industries | 2019 | [111] |
| Sr. No | Reducing Agent | Part of Plant | Size | Shape | Biological Activities | Year of Publication | Ref. |
|---|---|---|---|---|---|---|---|
| 1 | Parthenium hysterophorus | Seed | 10 nm | Hexagonal | - | 2020 | [112] |
| 2 | Lettuce | Seed | 50 nm | - | Effect on the process of seed germination | 2020 | [113] |
| 3 | Eriobotrya japonica | Seed | 50 nm | - | - | 2020 | [114] |
| 4 | Longan seed | Seed | 10–100 nm | Hexagonal | Evaluated through de-colorization of Orange II (70%), methylene blue (MB 90%), and methyl orange (80%) | 2019 | [115] |
| 5 | Trigonella foenum-graecum | Seed | 70–90 nm | Irregular spherical and flake | Potential application in agriculture and food industries | 2019 | [116] |
| Sr. No | Reducing Agent | Part of Plant | Size | Shape | Biological Activities | Year of Publication | Ref. |
|---|---|---|---|---|---|---|---|
| 1 | Passiflora foetida | Fruit peel | 58 nm | Hexagonal | Showed remarkable efficiency toward Rhodamine B (91.06%) and MB dye (93.25%) | 2021 | [117] |
| 2 | Myristica fragrans | Fruit | 41.23 nm | Spherical | E. coli (ZOI = 15 ± 1.54 mm), K. pneumoniae (ZOI = 27 ± 1.73 mm), P. aeruginosa (ZOI = 17 ± 1.66 mm), and S. aureus (ZOI = 21 ± mm) Exhibited excellent larvicidal activity against Aedes aegypti Leishmanicidal activity was also examined against amastigote and promastigote parasite | 2021 | [118] |
| 3 | Citrus sinensis | Fruit peel | 33.1 ± 11.7 | Hexagonal | E. coli and S. aureus. Toxicity toward human umbilical vein endothelial | 2020 | [119] |
| 4 | Orange | Fruit | 10–20 nm | Spherical | - | 2020 | [120] |
| 5 | Ailanthus altissima | Fruit | 5–18 nm | - | E. coli and S. aureus | 2019 | [121] |
| Sr. No | Reducing Agent | Part of Plant | Size | Shape | Biological Activities | Year of Publication | Ref. |
|---|---|---|---|---|---|---|---|
| 1 | Lantana camara, Populus alba, and Hibiscus arboreus | Leaf | ~16.3 ± 0.7 nm | - | E. coli and S. aureus (MIC value of ~100 µg/mL.) For the degradation of MB and CR dye | 2021 | [134] |
| 2 | Limnophila rugosa | Leaf | 122 nm | Spherical | Tremendous catalytic activity in the reduction of different nitrophenols | 2021 | [135] |
| 3 | Ananas comosus | Leaf | 18.85 ± 6.74 nm | Spherical | Exhibited a degradation efficacy of 90% after 240 hrs | 2021 | [136] |
| 4 | Phragmites australis | Leaf | 18 nm | Spherical | Showed tremendous anticancer efficiency. Exhibited good quenching for 2,2-diphenyl-1-picrylhydrazyl free radical with scavenging % equal to 10.26. Excellent photocatalytic activity, as they completely degraded the MB in just 60 sec. | 2021 | [137] |
| 5 | Mentha longifolia | Leaf | 36.4 nm | Spherical | Tremendous anti-breast cancer efficiency against HS319.T (IC50 = 224 ± 0 µg/mL), MCF7 (IC50 = 264 ± 0 µg/mL) and UACC-3133 (IC50 = 201 ± 0 µg/mL) cell lines | 2021 | [138] |
| 6 | Sageretia theazans | Leaf | 36 and 13 nm. | - | S. aureus (ZOI = 10 ± 0.54 mm), K. pneumonia (ZOI = 12 ± 0.2 mm), and B. subtilis (ZOI = 6 ± 0.4 mm). The antioxidant efficiency was investigated with DPPH scavenging activity, the maximum scavenging efficiency was observed at 100 µg/mL | 2021 | [139] |
| 7 | Coriandrum sativum | Leaf | 32.96 ± 5.25 nm | Spherical | - | 2021 | [139] |
| 8 | Persicaria salicifolia | Leaf | 5 and 23 nm | Spherica | Inhibiting the proliferation and growth of breast cancer cells (MCF7 cell line). Showed antioxidant activity | 2021 | [140] |
| 9 | Curcumae kwangsiensis | Leaf | ~8–25 nm | Spherical | Showed tremendous antioxidant property toward common free radical, e.g., BHT (IC50 = 153 µg/mL). Excellent anti-ovarian cancer activity against Sw-626 (IC50 = 166 µg/mL), SK-0V (IC50 = 204 µg/mL), and PA1 cell lines (IC50 = 153 µg/mL) | 2021 | [141] |
| 10 | Centaurea behen | Leaf | 50 nm | Spherical | Revealed cytotoxicity against THP-1 cell line. The IC50 for prepared nanoparticles was measured at about 25 µg/mL. Revealed maximum DPPH scavenging efficiency of 14% | 2021 | [142] |
| 11 | Ziziphus nummularia | Leaf | 11–12 nm | Spherical | Excellent antioxidant activity toward ABTS (IC50 = 690 μg/mL), DPPH (IC50 = 520 μg/mL), and SO (IC50 = 330 μg/mL). | 2021 | [143] |
| 12 | Jasminum auriculatum | Leaf | 8–37 nm | Spherical | E. coli, K. pneumonia, S. pyogenes, S. aureus, and Candida (fungus). Showed excellent Antimicrobial commotion toward Inhibitory effect in the proliferation of the human cervical cancer cell line (IC50 = 104 μg/mL). | 2020 | [144] |
| 13 | Vitex negundo | Leaf | Below 100 nm | Spherical rod-shaped | B. Subtilis (ZOI = 14 ± 0.7 mm), P. aeruginosa (ZOI = 13 ± 0.6 mm), S. aureus (ZOI = 12 ± 0.7 mm), and E. coli (ZOI = 23 ± 0.6 mm). Exhibited tremendous antioxidant activities against H2O2 (78%) scavenging, Nitric oxide scavenging (83%), and DPPH (79%). Exhibited tremendous anti-inflammatory activity. | 2020 | [145] |
| 14 | Pongamia pinnata | Leaf | 10–25 nm | - | Tested against oomycetes SR1(MIC80 = 1.6) and BP1120 (MIC80 = 0.8) | 2020 | [146] |
| 15 | Lactuca indica | Leaf | 13.5 nm | Spherical | Exhibited remarkable degradation of methyl orange (2.05 × 10−3) and 4-nitrophenol (1.3 × 10−3). | 2019 | [147] |
| 16 | Croton Caudatus | Leaf | 20 and 50 nm | Spherical | - | 2019 | [148] |
| 17 | Sansevieria roxburghiana | Leaf | - | Spherical, hexagonal, rod, and decahedral | Degradation of MB (49.62%), bromothymol blue 88.16%), acridine orange (40.44), phenol red (85.88), and Congo red (93.09). | 2019 | [149] |
| 18 | Simarouba glauca | Leaf | - | Prism and spherical | At 2.7 mL Gold solution S. aureus (ZOI = 2.0 mm), B. subtilis (ZOI = 1.0 mm), E. coli (ZOI = 0.6 mm), P. vulgaris (ZOI = 0.2 mm), K. pneumonia (ZOI = No), and S. mutans (ZOI = 1.6 mm). | 2019 | [150] |
| 19 | Alcea rosea | Leaf | 4–95 nm | Triangular, spherical, hexagonal, and pentagonal | Exhibited anti-oxidant commotion against ABTS (47.16 to 64.82%) and DPPH (15.95 to 51.53%) | 2019 | [151] |
| 20 | Bauhinia pupurea | Leaf | Hexagonal, nanorod, and triangular | B. Subtilis, P. aeruginosa, S. aureus, Anticancer effects toward Lung carcinoma cell A549 (IC50 = 36.39 μg/mL). Exhibited high antioxidant efficiency against DPPH (IC50 = 27.21 μg/mL). | 2019 | [152] | |
| 21 | Coleus aromaticus | Leaf | - | - | epidermis (ZOI = 27 mm) and E. coli (ZOI = 22 mm) Cytotoxicity toward liver cell (HepG2) cell line | 2019 | [153] |
| 22 | Annona muricata | Leaf | 25.5 nm | Spherical mono-dispersed | S. aureus (40%), E. faecalis (46%), K. pneumonia (52%), and C. sporogeneses (54%), flaws (31%), C. albicans (42%), F. oxysporum (50%), and P. camemberti (66%). | 2019 | [154] |
| Sr. No | Reducing Agent | Part of Plant | Size | Shape | Biological Activities | Year of Publication | Ref. |
|---|---|---|---|---|---|---|---|
| 1 | Licorice | Root | 2.647–16.25 nm | Circular | P. aeruginosa (ZOI = 25 ± 0.17), E. coli (ZOI = 29 ± 0.35), S. aureus (ZOI = 26 ± 0.29), S. typhi (ZOI = 26 ± 0.15), B. subtilis (ZOI = 25 ± 0. 15), P. citrinum (ZOI = 19 ± 0.21), A. niger (ZOI = 17 ± 0.29), Candida albicans (ZOI = 14 ± 0.21), F. oxysporum (ZOI = 18 ± 0.33), and A. flavus (ZOI = 16 ± 0.15). Antioxidant activity toward DPPH and ABTS. | 2021 | [155] |
| 2 | Phragmites australis | Root | - | - | Cytotoxicity toward human lung cancer cells (A549 cell line). Antioxidant efficiency was less than 10% | 2021 | [156] |
| 3 | Codonopsis pilosula | Root | 20 ± 3.2 nm | Spherical | E. coli (ZOI = 7.0 ± 0.42 mm), B. subtilis (ZOI = 12.0 ± 0.85 mm), and S. aureus (ZOI = 17.0 ± 1.2 mm). | 2020 | [157] |
| 4 | Euphorbia fischeriana | Root | 20–60 | - | - | 2019 | [158] |
| 5 | Paeonia moutan | Root | 25.08 ± 3.73 nm | - | Hindered the inflammation in murine microglial (BV2) | 2019 | [159] |
| Sr. No | Reducing Agent | Part of Plant | Size | Shape | Biological Activities | Year of Publication | Ref. |
|---|---|---|---|---|---|---|---|
| 1 | Brassica oleracea var. Acephala cv galega | Stem | 25.08 ± 3.73 nm | Spherical | The antioxidant assay was carried out in the root extract after the formation of gold nanoparticles | 2021 | [160] |
| 2 | Apium graveolens | Stem | - | - | Utilized as a catalyst for reduction of 4-nitophenol | 2020 | [161] |
| 3 | Angelica aiges | Stem | - | - | Degraded the Malachite (67%) and eosin dye (64%) | 2019 | [162] |
| Sr. No | Reducing Agent | Part of Plant | Size | Shape | Biological Activities | Year of Publication | Ref. |
|---|---|---|---|---|---|---|---|
| 1 | Saffron | Flower | - | - | - | 2021 | [163] |
| 2 | ClitoriaTernatea | Flower | 18.6 nm | Spherical | - | 2020 | [164] |
| 3 | Musa acuminata | Flower | 12.6–15.7 nm | - | K. pneumonia (ZOI = 12 mm), P. aeruginosa (ZOI = 9 mm), E. faecalis (ZOI = 10 mm), S. typhi (ZOI = NO), E. coli (ZOI = 7), S. aureus (ZOI = 11 mm), and P. mirabilis (ZOI = 12 mm). Exhibited antioxidant activity toward DPPH (IC50 = 390 μg for ethanol and 460 μg aqueous) | 2019 | [165] |
| 4 | Elettaria cardamomum | Seed | 16.6 nm | - | - | [166] |
| Sr. No | Reducing Agent | Part of Plant | Size | Shape | Biological Activities | Year of Publication | Ref. |
|---|---|---|---|---|---|---|---|
| 1 | Mentha longifolia | Leaf | 10.23 ± 2 nm | Round oval | At 2.0 (μg/mL) Concen of AgNPs S. aureus (ZOI = 12 ± 0.03 mm), B. subtilis (ZOI = 10 ± 0.01 mm), and K. pneumonia (ZOI = 0). | 2021 | [192] |
| 2 | Ocimum americanum | Leaf | 48.25 nm | - | At 100 (μg/mL) Concen of AgNPs S. aureus (ZOI = 18.33 ± 0.33 mm), P. aeruginosa (ZOI = 17.66 ± 0.66 mm), V. cholera (ZOI = 15.66 ± 0.88 mm), Aeromonas sp (ZOI = 13. 33 ± 0.33 mm), bacillus sp (ZOI = 16.33 ± 0.33 mm), and E. coli (ZOI = 7.66 ± 0.33 mm) Anti-oxidant activity was examined by H2O2 (58.71%) and DPPH (75%). Photocatalytic degradation of Eosin dye (91.17%) | 2021 | [193] |
| 3 | Clerodendrum inerme | Leaf | - | - | A. niger (ZOI = 17 mm), A. flavus (ZOI = 22 mm), and antibacterial i.e., B. subtilis (ZOI = 15 mm) and S. aureus (ZOI = 14 mm) The anti-oxidant and cytotoxic activities were also examined by utilizing DPPH free radical scavenging and MTT process (78.8 ± 0.19%) | 2020 | [194] |
| 4 | Salvia officinalis | Leaf | 41 nm | Spherical | Exhibited less cytotoxicity toward HeLa cells’ line and exhibited excellent anti-plasmodial efficiency (IC50 = 3.6 lg/mL) | 2021 | [195] |
| 5 | Alstonia venenata | Leaf | 27–36 nm | Spherical | The larvicidal efficiency on early-third-instar larvae was sufficiently higher for silver nanoparticles as compared to extract. The larvicidal activity was tested toward Culex quinquefasciatus with IC50 equivalent to 14.50 lg/mL, Anopheles stephensi with IC50 equivalent to12.28 lg/mL, and Aedes aegypti with equivalent to LC5013.49 lg/mL | 2021 | [196] |
| 6 | Sida retusa | Leaf | 20–40 nm. | Spherical | S. aureus (ZOI = 17 mm), B. subtilis (ZOI = 14 mm), E. coli (ZOI = 15 mm), and S. typhi (ZOI = 15 mm) | 2021 | [197] |
| 7 | Carica papaya | Leaf | - | - | Anticancer activity toward various human cancer cells. The cytotoxic commotion was performed toward various human cells and non-tumorigenic keratinocytes’ cells. Cure of DU145 cell with papaya-mediated silver nanoparticles (0.5–5.0 μg/mL) for 1 or 2 days decreased the total cell number by 21–36% | 2021 | [198] |
| 8 | Carissa carandas | Leaf | 35 ± 2 nm at 25 °C and 30 ± 3 nm at 60 | - | E. faecalis (ZOI = 7.0 ± 0.0 mm), S. flexneri (ZOI = 8.0 ± 1.0 mm), S. typhimurium (ZOI = 8.0 ± 1.0 mm), and gonococci spp (ZOI = 6.0 ± 0.0 mm) Exhibited excellent antioxidant activity through DPPH assay (IC50 = 68.12 ± 1.27). | 2021 | [199] |
| 9 | Malva parviflora | Leaf | 50.6 nm | Spherical | Inhibited the growth of F. oxysporum (81%), A. alternate (82%), H. rostratum (89%), and F. solani (81%). | 2021 | [200] |
| 10 | Ziziphus nummularia | Leaf | 25.6 nm | Oval and Spherical | Exhibited good DPPH activity (IC50 = 520 mg/mL) and ABTS activity (IC50 = 55 mg/mL) | 2021 | [201] |
| 11 | Otostegia persica | Leaf | 36.5 ± 2.0 nm | Spherical | S. pyogenes (ZOI = 14 ± 0.4 mm), S. aureus (ZOI = 16 ± 0.1 mm), B. subtilis (ZOI = 15 ± 0.3 mm), P. aeruginosa (ZOI = 21 ± 0.5 mm), S. typhi (ZOI = 19 ± 0.4 mm), and E. coli (ZOI = 17 ± 0.1 mm) Exhibited excellent anti-oxidant activity (84%) compared to Otostegia persica leaf extract (64%). | 2021 | [202] |
| 12 | Lotus lalambensis | Leaf | - | - | C. albicans (MIC = 125 μg/mL) | 2021 | [203] |
| 13 | Symplocos racemosa | Leaf | - | - | P. aeruginosa (ZOI = 22 mm) | 2021 | [204] |
| 14 | Aloe vera | Leaf | - | - | P. aeruginosa (ZOI = 14.00 ± 1.00 mm), S. aureus (ZOI = 21.00 ± 1.00 mm), E. coli (ZOI = 20.00 ± 2.00 mm), and Enterobacter sp (ZOI = 32.00 ± 2.00 mm) | 2021 | [205] |
| 15 | Ruellia tuberosa. | Leaf | 55.65 nm | Spherical | Cytotoxic potency against A549 lung cancer line with IC50 = 68 μg/mL. Degraded the Coomassie brilliant blue and crystal violet absorbance (peaks of the degraded CV and CBB were recorded at 586 and 590 nm) | 2021 | [206] |
| 16 | Psidium guajava | Leaf | - | - | Anti-chikungunya potency | 2021 | [207] |
| 17 | Euphorbia sanguinea | Leaf | - | - | Photocatalytic degradation of CR (90% within 1 h) | 2021 | [208] |
| Sr. No | Reducing Agent | Part of Plant | Size | Shape | Biological Activities | Year of Publication | Ref. |
|---|---|---|---|---|---|---|---|
| 1 | Borago officinalis | Leaf | 40 nm | Irregular | The bio-synthesized silver nanoparticles were hazardous to Spodoptera littoralis | 2020 | [209] |
| 2 | Tragopogon collinus | Leaf | 7 nm | - | At 6000 (μg/mL) Concen of AgNPs S. aureus (ZOI = 2 mm) and E. coli (ZOI = 4 mm) At 7000 (μg/mL) Concen of AgNPs S. aureus (ZOI = 5 mm) and E. coli (ZOI = 7 mm) At 8000 (μg/mL) Concen of AgNPs S. aureus (ZOI = 10 m) and E. coli (ZOI = 8 mm) | 2020 | [210] |
| 3 | Melia azedarach | Leaf | 18–30 nm | Spherical | Verticillium dahlia | 2020 | [211] |
| 4 | Mentha aquatica | Leaf | 41 nm | Spherical | P. aeruginosa (MIC = 2.2μg/mL), E. coli (MIC = 58μg/mL), B. cereus (MIC = 20), and S. aureus (MIC = 198μg/mL) | 2020 | [212] |
| 5 | Ziziphus joazeiro. | Leaf | - | - | E. coli ATCC 25922 and S. aureus ATCC 25923 | 2020 | [213] |
| 6 | Elytraria acaulis | Leaf | 5–100 nm | Cuboid | S. typhi (ZOI = 11.5 ± 2.5 mm), S. Epidermis (ZOI = 14.3 ± 1.7 mm), E. coli (ZOI = 11.2 ± 1.6 mm), and B. subtilis (ZOI = 12.0 ± 2.4 mm). Anti-oxidant activity toward DPPH (84.47%) and ABTS (85.25%) Cytotoxic commotion was performed against A549 cell line (IC50 = 79.6 µg/mL) | 2020 | [214] |
| 7 | Hyptis suaveolens | Leaf | 29.19–52.27 nm | - | Scavenged H2O2 (54.21–70.11%) and DPPH (77.75–83.19) Stopped coagulation of blood | 2020 | [215] |
| 8 | Caesalpinia pulcherrima | Leaf | 9 nm | Spherical | Cytotoxicity toward HeLa cell line (IC50 = 4.44 mg/mL) | 2020 | [216] |
| 9 | Gomphrena globosa | Leaf | - | Spherical | subtilis (ZOI = 40 mm), P. aeruginosa (ZOI = 38 mm), M. luteus (ZOI = 48 mm), E. coli (ZOI = 53 mm), and K. pneumonia (ZOI = 39 mm) | 2020 | [217] |
| 10 | Plumbago auriculata | Leaf | 20 to 500 nm | - | At 5 (μg/mL) Concen of AgNPs S. aureus (ZOI = 10 ± 1.5 mm), B. subtilis (ZOI = 8 ± 0.5 mm), K. pneumonia (ZOI = 11 ± 0.5 mm), and E. coli (ZOI = 10 ± 0.8 mm), At 10 (μg/mL) Concen of AgNPs S. aureus (ZOI = 10 ± 0.8 mm), B. subtilis (ZOI = 10 ± 1.7 mm), K. pneumonia (ZOI = 11 ± 0.8 mm), and E. coli (ZOI = 10 ± 0.6 mm), At 15 (μg/mL) Concen of AgNPs S. aureus (ZOI = 8 ± 0.7 mm), B. subtilis (ZOI = 8 ± 0.9 mm), K. pneumonia (ZOI = 12 ± 1.0 mm), and E. coli (ZOI = 12 ± 1.0 mm), At 20 (μg/mL) Concen of AgNPs S. aureus (ZOI = 10 ± 1.5 mm), B. subtilis (ZOI = 8 ± 1.0 mm), K. pneumonia (ZOI = 14 ± 1.7 mm), and E. coli (ZOI = 12 ± 2.5 mm), Inhibited the growth of Culex quinquefasciatus (45.1 µg/mL) and Aedes aegypti | 2020 | [218] |
| 11 | Cucumis prophetarum | Leaf | 30–50 nm | - | At 20 (μg/mL) Concen of AgNPs S. typhi (ZOI = 15 ± 0.2 mm) and S. aureus (ZOI = 11 ± 0.4 mm) At 50 (μg/mL) Concen of AgNPs S. typhi (ZOI = 17 ± 0.5 mm) and S. aureus (ZOI = 14 ± 0.3 mm) At 75 (μg/mL) Concen of AgNPs S. typhi (ZOI = 20 ± 0.6 mm) and S. aureus (ZOI = 18 ± 0.4 mm) Anti-oxidant activity toward DPPH (IC50 = 29.2 µg/mL) and ABTS (IC50 = 34.5µg/mL) | 2020 | [219] |
| 12 | Polygonatum graminifolium | Leaf | 3–15 nm | Spherical | E. coli (ZOI = 27 mm) and S. aureus (ZOI = 16 mm) | 2020 | [220] |
| 13 | Cocos nucifera | Leaf | 14.2 nm | Cubic | E. coli (ZOI = 16.0 ± 0.11 mm), B. subtilis (ZOI = 10.0 ± 0.05 mm), S. aureus (ZOI = 12.0 ± 0.06 mm), and S. typhimurium (ZOI = 13.0 ± 0.12 mm), | 2020 | [221] |
| 14 | Mimosa albida | Leaf | 6.5 nm ± 3.1 nm | - | Exhibited anti-oxidant activity (IC50 = 7563 ± 967) | 2020 | [222] |
| 15 | Capparis zeylanica | Leaf | - | Spherical | S. Paratyphi (ZOI = 18 mm), S. dysenteriae (ZOI = 19 mm), S. epidermidis (ZOI = 22 mm), E. faecalis (ZOI = 20 mm), A. niger (ZOI = 21 mm), and C. albicans (ZOI = 20 mm) | 2020 | [223] |
| 16 | Holoptelea integrifolia | Leaf | 32–38 nm. | Spherical | Showed antioxidant activities toward DPPH (74.59 ± 3.08%) Showed antiinflammatory (binding constant 2.60 ± 0.05 × 10−4) and antidiabetic (86.66 ± 5.03%) activities. | 2019 | [224] |
| 17 | Annona reticulatal | Leaf | - | Cubic | P. Aeruginosa (MIC = 62.5 μg/mL), E. coli (MIC = 62.6 μg/mL), S. aureus (MIC = 31.5 μg/mL), B. cereus (MIC = 125 μg/mL), and C. albicans (MIC = 62.5 μg/mL) | 2019 | [225] |
| 18 | Combretum erythrophyllum | Leaf | 13.62 nm | Spherical | S. Epidermidis (ZOI = 12 mm), P. vulgaris (ZOI = 11 mm), S. aureus (ZOI = 15 mm), and E. coli (ZOI = 12 mm) | 2019 | [226] |
| 19 | Berberis vulgaris | Leaf | 30–70 nm | Spherical | S. aureus and E. coli | 2019 | [227] |
| 20 | Catharanthus roseus | Leaf | - | - | P. Aeruginosa (ZOI = 6 mm), S. dysenteriae (ZOI = 8 mm), S. aureus (ZOI = 8 mm), and B. anthracis (ZOI = 12 mm), | 2019 | [228] |
| 21 | Ganonerion polymorphum | Leaf | 20–60 nm | Hexagonal and Spherical | B. Cereus (99.75%) and E. coli (99.94%) | 2019 | [229] |
| 22 | Premna integrifoliaL | Leaf | 9–35 nm | Spherical | E. faecalis (MIC = 60 μg/mL), V. parahaemolyticus (MIC = 10 μg/mL), S. dysenteriae (MIC = 20 μg/mL), S. aureus (MIC = 30 μg/mL), and S. flexneri (MIC = 70 μg/mL) Showed anti-oxidant activity (IC50 = 524.19 ± 2.63 µg/mL) and cytotoxic to cancer cell line (SiHa). | 2019 | [230] |
| 23 | Piper betle | Leaf | 6–14 nm | Spherical | At 1000 (μg/mL) Concen of AgNPsF. Solani (ZOI = 3.13 ± 0.25 mm) and A. brassicae (ZOI = 67. 21 ± 3.15 mm) | 2019 | [231] |
| Sr. No | Reducing Agent | Part of Plant | Size | Shape | Biological Activities | Year of Publication | Ref. |
|---|---|---|---|---|---|---|---|
| 1 | Ricinus communis | Root | 29 nm | Spherical | E. coli (73%), K. pneumonia (60%), S. aureus (56%), S. pneumonia (60%), A. niger (77%), and A. alternate (75%) Exhibited remarkable efficiency toward Urease (IC50 = 36.81 ± 0.05 μg/mL) and Xanthine (IC50 = 3.60 ± 0.04 μg/mL) | 2021 | [232] |
| 2 | Duchesnea indica | Root | 20.49 nm | Spherical | E. coli (MIC = 0.53 mg/mL), S. typhi (MIC = 0.01 mg/mL), A. alternate (MIC = 0.51 mg/mL), and M. canis (MIC = 0.53 mg/mL) | 2021 | [233] |
| 3 | Salvadora persica | Root | 37.5 nm | Rod and Spherical | S. epidermidis ATCC12228 (MIC = 0.39 µg/mL) and E. coli (MIC = 0.19 µg/mL) | 2021 | [234] |
| 4 | Asparagus officinalis | Root | - | - | Cytotoxic toward cervical cancer cell line (SiHa) (IC50 = 44 lg mL−1) | 2021 | [235] |
| 5 | Astragalus tribuloides Delile | Root | 34.2 ± 8.0 nm | Spherical | S. aureus (ZOI = 18 mm), S. flexneri (ZOI = 27 mm), E. coli (ZOI = 24 mm), and B. cereus (ZOI = 16 mm) Excellent anti-oxidant (64% property higher than extract (47%) | 2020 | [236] |
| 6 | Berberis asiatica | Root | 14 nm | Spherical | S. typhimurium (ZOI = 7 mm), E. coli (ZOI = 11 mm), S. aureus (ZOI = 12 mm), and K. pneumonia (ZOI = 6 mm) | 2020 | [237] |
| Sr. No | Reducing Agent | Part of Plant | Size | Shape | Biological Activities | Year of Publication | Ref. |
|---|---|---|---|---|---|---|---|
| 1 | Grewia lasiocarpa | Stem bark | diameter between 38.3 and 46.7 nm | Spherical | S. aureus (MIC = 15.67 ± 2.08 µg/mL). Exhibited cytotoxicity toward HeLa (IC50 = > 1 μg/mL). | 2021 | [238] |
| 2 | Euphorbia nivulia | Stem bark | 20–90 nm | Spherical | K. pneumoniae (MIC = 23.5 ± o.5 µg/mL), B. cereus (MIC = 27 ± 1 µg/mL), S. aureus (MIC = 24.5 ± 1.5 µg/mL), P. aeruginosa (MIC = 30.5 ± 0.5 µg/mL), B. subtilis (MIC = 29 ± 1 µg/mL), and C. albicans (MIC = 26 ± 1 µg/mL) | 2021 | [239] |
| 3 | Boswellia dalzielii | Stem | 2 nm to 101 nm | - | Anti-oxidant activity of prepared silver nanoparticles was tested using DPPH (TEAC = 300.91) | 2020 | [240] |
| 4 | Piper chaba | Stem | 19 nm | Spherical | Degradation of MB and reduction of 4-nitrppheno | 2020 | [241] |
| 5 | Garcinia kola | Stem | - | - | E. faecalis (ZOI = 2 mm), B. cereus (ZOI = 4 mm), C. sporogenes (ZOI = 6 mm), and E. coli (ZOI = 10 mm) | 2020 | [242] |
| 6 | Vigna unguiculata | Stem | ~25 nm | - | - | 2019 | [243] |
| Sr. No | Reducing Agent | Part of Plant | Size | Shape | Biological Activities | Year of Publication | Ref. |
|---|---|---|---|---|---|---|---|
| 1 | Trigonella foenum-graecum | Seed | - | - | B. cereus (ZOI = 10 mm), E. coli (ZOI = 14 mm), and S. aureus (ZOI = 5.0 mm) | 2021 | [244] |
| 2 | Morinda citrifolia | Seed | 3 nm | Spherical | S. aureus (ZOI = 9.81 mm) and E. coli (ZOI = 10.63 mm) | 2021 | [245] |
| 3 | Mangifera indica | Seed | - | - | B. cereus (ATCC11778) (K. pneumonia (NMCIM2719), S. aureus (ATCC29737), P. aeruginosa (ATCC9027), C. rubrum (ATCC14898), E. coli (NCIM2931), S. typhimurium (ATCC23564), C. neoformans (ATCC34664), C. albicans (ATCC2091), and C. glabrata (NCIM3438) | 2021 | [246] |
| 4 | Annona squamosa L. | Seed | 22 nm | Spherical | Showed excellent catalytic activity against degradation of Coomassie brilliant blue dye | 2021 | [247] |
| 5 | Rosa canina | Seed | 150 nm | Rod and Spherical | - | 2021 | [248] |
| 6 | Nigella sativa | Seed | - | - | Showed good photocatalytic activity on degradation of Congo red (Degraded 96%, 97%, and 98.5%, at 0.2, 0.15, and 1.3 min, respectively). | 2021 | [249] |
| 7 | Moringa oleifera | Seed | - | Spherical | Enhanced wound contraction and tissue growth wall | 2021 | [250] |
| 8 | Bunium persicum | Seed | 35 to 70 nm | - | Inhibited Urease and tyrosinase | 2021 | [251] |
| 9 | Syzygium cumini | Seed | - | - | F. nucleatum (MIC = NO), A. naeslundii (MIC = 125 µg/mL), S. aureus (MIC = 125 µg/mL), S. mutans (MIC = 250 µg/mL), S. epidermidis (MIC = 31.2 µg/mL), V. dispar (MIC = 62.5 µg/mL), and S. oralis (MIC = 31.2 µg/mL) | 2021 | [252] |
| 10 | Vitis vinifera | Seed | 10–50 nm | - | - | 2021 | [253] |
| 11 | Gingerand Nigella sativa | Seed | ~12–8 nm | - | P. Aeruginosa and E. coli | 2020 | [254] |
| 12 | Cuminum cyminum L. | Seed | ~100 nm | Spherical | Effective against human breast cancer cells (IC50 = 1.25 µg/mL) | 2020 | [255] |
| 13 | Punica granatum | Seed | 10 to 35 nm | Spherical | - | 2020 | [256] |
| 14 | Salvia hispanicaL. | Seed | 7 nm | Spherical | S. aureus (ZOI = 14.9 mm) and E. coli (ZOI = 18.5 mm) | 2019 | [257] |
| 15 | Avicennia marina | Seed | 5–10 nm | - | pneumoniae ATCC 700,603 (ZOI = 12.5 ± 0.01 mm), E. faecalis ATCC 5129 (ZOI = No), S. aureus ATCC 43,300 (ZOI = 3.25 ± 0.02 mm), P. aeruginosa ATCC 27,853 (ZOI = 12.5 ± 0.05 mm), and E. coli ATCC 35,218 (ZOI = 6.25 ± 0.05 mm) | 2019 | [258] |
| 16 | Tectona grandis | Seed | 10–30 nm | - | B. cereus (ZOI = 12 mm), E. coli (ZOI = 17 mm), and S. aureus (ZOI = 16 mm) | 2019 | [259] |
| Sr. No | Reducing Agent | Part of Plant | Size | Shape | Biological Activities | Year of Publication | Ref. |
|---|---|---|---|---|---|---|---|
| 1 | Avera lanata | Flower | 7.6 nm | - | DPPH radical scavenging analysis showed antioxidant activity of prepared silver nanoparticles (IC50 = 50.08 ± 3.34) | 2021 | [260] |
| 2 | Fraxinus excelsior | Flower | - | - | Used as environmentally friendly material for the coloration of woven glass fabrics | 2021 | [261] |
| 3 | Jasmine | Flower | 40 nm | - | Prepared silver nanoparticles degraded the MB (78% after 120 min). | 2021 | [262] |
| Sr. No | Reducing Agent | Part of Plant | Size | Shape | Biological Activities | Year of Publication | Ref. |
|---|---|---|---|---|---|---|---|
| 1 | Mentha arvensis | Leaf | 20–70 nm | Spherical | At 10 (μg/mL) Concen of AgNPs P. Vulgaris (ZOI = 25 mm), E. coli (ZOI = 20 mm), S. aureus (ZOI = 21 mm), A. niger (ZOI = No), A. fumigates (ZOI = 6 mm), and A. cuboid (ZOI = No) | 2021 | [275] |
| 2 | Pouteria campechiana | Leaf | - | Spherical | Exhibited larvicidal activity toward Aedes aegypti | 2021 | [276] |
| 3 | Coleus aromaticus | Leaf | 12–33 nm | Hexagonal | S. boydii (ZOI = 30 mm) and E. faecalis (ZOI = 33 mm) Larvicidal activity toward fourth stages of instars’ larvae of Aedes aegypti. Cytotoxic activity toward HeLa cell line | 2021 | [277] |
| 4 | Ochradenusarabicusis | Leaf | 20–40 nm | - | S. aureus (MIC = 31.25 µg/mL) and P. aeruginosa (MIC = 128 µg/mL) | 2021 | [278] |
| 5 | Aegle marmelos | Leaf | 150 nm | Spherical | Removed ornidazole from wastewater. | 2020 | [279] |
| 6 | Azadirachta indica | Leaf | 25–87 nm | Spherical | B. subtilis (MIC = 25 μg/mL), E. coli (MIC = 10.42 μg/mL), K. pneumoniae (MIC = 16.66 μg/mL), and S. typhi (MIC = 10.42 μg/mL). | 2019 | [280] |
| 7 | Carica papaya | Leaf | 20 nm | Spherical | Photocatalytic activity (91.19%) against degradation of RO-4 dye | 2019 | [281] |
| 8 | Aloe barbadensis | Leaf | ~20 nm | Spherical | Anti-biofilm activity toward P. aeruginosa (ZOI = 30.69 ± 3.78 mm) | 2019 | [282] |
| 9 | Glycyrrhiza glabra | Root | 69 nm | Spherical | Cytotoxicity toward HEP2 and vero cell line | 2019 | [283] |
| 10 | Jasmine | Flower | 31–42 nm | Spherical | Exhibited excellent degradation toward methylene blue dye (92% after 120 min). | 2021 | [284] |
| 11 | Myristica fragrans | Seed | - | - | Showed degradation against Congo red (99% after 45 min) and methylene blue (97% after 60 min). | 2021 | [285] |
| 12 | Cuminum cyminum | Seed | 15.17 nm | - | - | 2021 | [286] |
| 13 | Trachyspermum ammi | Seed | 16.63 nm | Spherical and spheroidal | - | 2021 | [287] |
| 14 | Bixa orellana | Seed | 13 ± 2 nm | Spherical | - | 2019 | [288] |
| 15 | Nephelium lappaceumL. | Fruit peel | 70–90 nm | - | Cytotoxicity was tested against MDA-MB-231 (death rate of cell = 73.65 µg/mL) | 2019 | [288] |
| Sr. No | Reducing Agent | Part of Plant | Size | Cu/CuO NPs | Shape | Biological Activities | Year of Publication | Ref. |
|---|---|---|---|---|---|---|---|---|
| 1 | Terminalia chebula | Leaf | 100 nm | CuO | Rod-like shape | Applications on diesel engine. | 2021 | [301] |
| 2 | Cedrus deodara | Leaf | 100 nm | CuO | Spherical | S. aureus (MIC = 25 lg∕mL) and E. coli (MIC = 150 lg∕mL) | 2021 | [302] |
| 3 | Psidium guajava | Leaf | 40–150 nm | CuO | Oval | epidermis (ZOI = 1.8 mm), E. coli (ZOI = 2 mm), S. pneumoniae (ZOI = 1.4 mm), and P. aeruginosa (ZOI = 3 mm) | 2021 | [303] |
| 4 | Sesbania aculeata | Leaf | - | Cu | - | C. lunata (ZOI = 22 mm) and Phoma destructiva (ZOI = 23 mm) | [304] | |
| 5 | Celastrus paniculatus | Leaf | 2–10 nm | CuO | Spherical | F. Oxysporum (maximum mycelial inhibition = 76.29 mm) | 2020 | [305] |
| 6 | Catha edulis | Leaf | - | CuO | Spherical | K. Pneumonia (ZOI = 29 ± 0.03 mm), E. coli (ZOI = 32 ± 0.02 mm), S. aureus (ZOI = 22 ± 0.01 mm), and S. pyogenes (ZOI = 24 ± 0.02 mm) | 2020 | [306] |
| 7 | Ageratum houstonianumMill | Leaf | ~80 nm | Cu | Cubic, rectangular, hexagonal | E. coli (ZOI = 12.43 ± 0.233 mm). Photocatalytic property of prepared particles was tested toward an azo dye Congo red (40%). | 2020 | [307] |
| 8 | Jatropha curcas | Leaf | 10 ± 1 and 12 ± 1 nm | Cu | - | Photocatalytic activity toward methylene blue (70%) | 2020 | [308] |
| 9 | Citrofortunella microcarpa | Leaf | - | CuO | - | Photocatalytic activity against Rhodamin B (98%) | 2020 | [309] |
| 10 | Enicostemma axillare | Leaf | 330 nm | CuO | - | - | 2019 | [310] |
| 11 | Camelia sinensis | Leaf | 60 ± 6 nm | CU | Spherical | Photocatalytic degradation (83.7%) of prepared copper nanoparticles was tested by utilizing bromophenol blue | 2019 | [311] |
| 12 | Annona squamosa | Seed | - | CuO | Spherical | Microbacterium testaceum (ZOI = 17 mm) and E. coli (ZOI = 21 mm) | 2021 | [312] |
| 13 | Azadirachta indica | Seed | 41 ± 21 nm | CuO | - | Positive effect on nutrition, growth, and enhanced seed germination | 2020 | [313] |
| 14 | Elettaria cardamom | Seed | 1–100 nm | CuO | - | - | 2020 | [314] |
| 15 | Wheat | Seed | 22 ± 1.5 nm | CuO | Spherical | Described catalytic activity toward 4-nitrophenol removal (97.6% after 5 days) | 2019 | [315] |
| 16 | Ocimum tenuiflorum | Flower | 5–10 nm | Cu | Spherical | Amino acid detection | 2019 | [316] |
| 17 | Stachys Lavandulifolia | Flower | 20–25 nm | CuO | Spherical | - | 2021 | [317] |
| 18 | Punica granatum | Fruit peel | 38.50 nm | CuO | - | - | 2020 | [318] |
| Sr. No | Reducing Agent | Part of Plant | Size | Iron/Iron Oxide NPs | Shape | Biological Activities | Year of Publication | Ref. |
|---|---|---|---|---|---|---|---|---|
| 1 | Romalina sinensis | Leaf | 20–70 nm | Iron Oxide | Spherical | - | 2021 | [322] |
| 2 | Chlorophytum comosum | Leaf | 100 nm | Iron | - | P. aeruginosa, E. faecalis, E. coli, and S. aureus. The prepared iron nanoparticles showed Methyl orange degradation (77% after 7 h) | 2021 | [323] |
| 3 | Laurus nobilis | Leaf | 8.03 ± 8.99 nm | Iron Oxide | Spherical and hexagonal | E. coli (ZOI = No), L. monocytogenes (ZOI = 12 mm), S. aureus (ZOI = No), P. spinulosum (ZOI = 14 mm), and A. aspergillus (ZOI = 13 mm) | 2020 | [324] |
| 4 | Carica papaya | Leaf | - | Iron Oxide | - | S. aureus (ZOI = 14 mm), Klebsiella spp (ZOI = 9 mm), and E. coli (ZOI = 9 mm). Exhibited against BHK-21 and Hela cell lines | 2020 | [325] |
| 5 | Eucalyptus robusta | Leaf | - | Iron | - | S. aureus (ZOI = 1.15 ± 0.05 mm), B. subtilis (ZOI = 3.60 ± 0.40 mm), P. aeruginosa (ZOI = 29 ± 0.03 mm), and E. coli (ZOI = 1.10 ± 0.10 mm) | 2020 | [326] |
| 6 | Ruellia tuberosa | Leaf | 52.78 nm | Iron Oxide | - | K. pneumonia (ZOI = 12 mm) and E. coli (ZOI = 17 mm) | 2019 | [327] |
| 7 | Avicennia marine | Flower | 30–100 nm | Iron oxide | Honeycomb | - | 2021 | [328] |
| 8 | Punica granatum | Seed | 25–55nm | Iron oxide | Semi spherical | Exhibited efficient degradation toward reactive blue (95.08% after 56 min) | 2019 | [329] |
| 9 | Borassusflabellifer | Seed | 10–40 nm | Iron oxide | Hexagonal | At 50 (μg/mL) Concen of Fe2O3NPs B. subtilis (ZOI = 18 mm), E. coli (ZOI = 14 mm), S. aureus (ZOI = 11 mm), C. albicans (ZOI = 9 mm), and A. niger (ZOI = 9 mm) At 100 (μg/mL) Concen of Fe2O3NPs C. subtilis (ZOI = 24 mm), E. coli (ZOI = 14 mm), S. aureus (ZOI = 18 mm), C. albicans (ZOI = 10 mm), and A. niger (ZOI = 11 mm) At 500 (μg/mL) Concen of Fe2O3NPs B. subtilis (ZOI = 26 mm), E. coli (ZOI = 23 mm), S. aureus (ZOI = 20 mm), C. albicans (ZOI = 13 mm), and A. niger (ZOI = 15 mm) | 2020 | [330] |
| 10 | Iraqi grapes | Fruit | 29–37 nm | Iron oxide | - | E. coli (ZOI = 19 mm) and S. aureus (ZOI = 18 mm) | 2020 | [331] |
| 11 | Cornelian cherry | Fruit | 20–40 nm | Iron oxide | Spherical | - | 2020 | [333] |
| Sr. No | Reducing Agent | Part of Plant | Size | Cobalt/Cobalt Oxide NPs | Shape | Biological Activities | Year of Publication | Ref. |
|---|---|---|---|---|---|---|---|---|
| 1 | Hibiscus rosa sinensis | Leaf | - | Co3O4 | - | P. aeruginosa (ZOI = 20 ± 1.47 mm), E. coli (ZOI = 16 ± 1.61 mm), and Proteus vulgaris (ZOI = 21 ± 1.32 mm) | 2021 | [340] |
| 2 | Conocarpus erectus L | Leaf | 4.9 nm | Co | Spherical | - | 2021 | [341] |
| 3 | Citrus medica | Leaf | 100 nm | Co3O4 | - | Degradation of methyl orange (90% after 1 h) | 2021 | [342] |
| 4 | Foenum-graceum L. | Leaf | 13.2 nm | Co3O4 | Quasi-spherical | - | 2020 | [343] |
| 5 | Populus ciliata | Leaf | - | Co3O4 | - | At 2(mg/mL) Concen of CoNPs B. Lichenifermis (ZOI = 14.1 ± 0.4 mm), E. coli (ZOI = 1.10 ± 0.5 mm), B. subtilis (ZOI = 19.7 ± 0.4 mm), and K. pneumonia (ZOI = 12.8 ± 0.2 mm) At 4(mg/mL) Concen of CoNPs B. Lichenifermis (ZOI = 19.2 ± 1.2 mm), E. coli (ZOI = 15.1 ± 0.6 mm), B. subtilis (ZOI = 21.2 ± 0.5 mm), and K. pneumonia (ZOI = 17.8 ± 0.9 mm) At 2(mg/mL) Concen of CoNPs B. Lichenifermis (ZOI = 22.5 ± 0.9 mm), E. coli (ZOI = 16.0 ± 0.8 mm), B. subtilis ZOI = 24.5 ± 1.3 mm), and K. pneumonia (ZOI = 20.4 ± 0.7 mm) | 2020 | [344] |
| 6 | Selinum wallichianum | Leaf | - | Co | - | - | 2019 | [345] |
Publisher’s Note: MDPI stays neutral with regard to jurisdictional claims in published maps and institutional affiliations. |
© 2021 by the authors. Licensee MDPI, Basel, Switzerland. This article is an open access article distributed under the terms and conditions of the Creative Commons Attribution (CC BY) license (https://creativecommons.org/licenses/by/4.0/).
Share and Cite
Bukhari, A.; Ijaz, I.; Gilani, E.; Nazir, A.; Zain, H.; Saeed, R.; Alarfaji, S.S.; Hussain, S.; Aftab, R.; Naseer, Y. Green Synthesis of Metal and Metal Oxide Nanoparticles Using Different Plants’ Parts for Antimicrobial Activity and Anticancer Activity: A Review Article. Coatings 2021, 11, 1374. https://doi.org/10.3390/coatings11111374
Bukhari A, Ijaz I, Gilani E, Nazir A, Zain H, Saeed R, Alarfaji SS, Hussain S, Aftab R, Naseer Y. Green Synthesis of Metal and Metal Oxide Nanoparticles Using Different Plants’ Parts for Antimicrobial Activity and Anticancer Activity: A Review Article. Coatings. 2021; 11(11):1374. https://doi.org/10.3390/coatings11111374
Chicago/Turabian StyleBukhari, Aysha, Irfan Ijaz, Ezaz Gilani, Ammara Nazir, Hina Zain, Ramsha Saeed, Saleh S. Alarfaji, Sajjad Hussain, Rizwana Aftab, and Yasra Naseer. 2021. "Green Synthesis of Metal and Metal Oxide Nanoparticles Using Different Plants’ Parts for Antimicrobial Activity and Anticancer Activity: A Review Article" Coatings 11, no. 11: 1374. https://doi.org/10.3390/coatings11111374
APA StyleBukhari, A., Ijaz, I., Gilani, E., Nazir, A., Zain, H., Saeed, R., Alarfaji, S. S., Hussain, S., Aftab, R., & Naseer, Y. (2021). Green Synthesis of Metal and Metal Oxide Nanoparticles Using Different Plants’ Parts for Antimicrobial Activity and Anticancer Activity: A Review Article. Coatings, 11(11), 1374. https://doi.org/10.3390/coatings11111374







